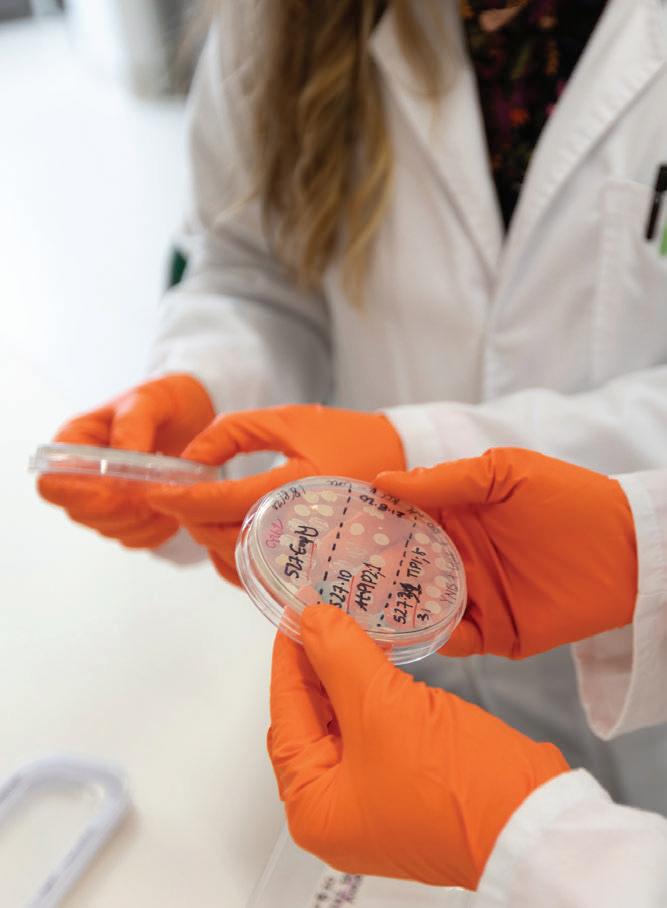

Walking the thin RED line
By Inside Waste
When the news broke that soft plastics collection business REDcycle had been storing soft plastics it had been collecting from Coles and Woolworths, company founder Liz Kasell knew it wasn’t a good look. Starting from an inkling of an idea she had 10 years ago, the scheme had grown too big, too fast – exacerbated by the COVID-19 pandemic.
The company recently went into liquidation despite Kasell and her team’s best efforts to make things right. So, what went wrong?

To find out, you need to start at the beginning of the end – when the news broke in the mainstream media about soft plastic bales being stockpiled in warehouses throughout Victoria and New South Wales.



It wasn’t that the bales of soft plastics had been found – after all there was no deliberate attempt to hide them – but the perception amplified by an over-excited media that inferred there were nefarious
reasons for the stockpiling. While Kasell readily admits REDcycle could have done things differently, she has not stopped working to find, and help build, end-markets for the plastics and to negate the partisan narrative that had been in the public arena.
To understand how the warehouse situation unfolded, you must go back the best part of 24 months during COVID. Kasell describes it as a perfect storm in terms of the timeline and how things happened.
COVID has been blamed for a lot of events and outcomes over the past three years – whether it be supply chain issues, supermarkets running out of stock, and a downturn in business for industries such as travel and hospitality. When it comes to the waste industry, there haven’t been too many knock-on effects, other than staffing shortages in some areas. With REDcycle, there was an opposite effect – too much feedstock.
“All of a sudden, all of our downstream capacity was affected,” Kasell said. “For five years, we knew for example, a bin would get
filled once a day, every day. We knew that bin was going to get filled seven times a week and so we allocated that much space all the way through the pipeline.
“Then, due to people staying at home all day through COVID, those bins were filling 12 times a day, or 15 times a day. If you multiply that by over a thousand locations, you realise the volumes I am talking about.
(Continued on page 21)
28 A new way to sort waste 34 No butts
36 Focus on FOGO

NSW EPA focussed on collaboration
ONE of the first things Tony Chappel did when he became the CEO of the NSW EPA was give a speech at the 2022 Australian Waste and Recycling Expo (AWRE), where he talked about “collective” collaboration between the state government, and waste and resource recovery stakeholders.
Nine months down the track, how is that collaboration panning out?

“I’ve been a little surprised by some of the entrenched positions, both within industry and the EPA itself.

“Changing the way we work with industry and transitioning to a more collaborative approach isn’t going to happen overnight, it will take time and commitment but I firmly believe it will achieve the best outcomes for the environment, economy and communities.
“The real focus is trying to look for opportunities to bring that conversation into the light and get people talking more productively.”
Arriving in Australia from South Africa when he was two, the now ‘Ausified’ Chappel’s tertiary education includes a raft of degrees – a Bachelor of Laws and Economics from Sydney University, a Masters In Environmental Change and Management from the University of Oxford, as well as another Masters, this time in Environmental Engineering Technology/Environmental Technology from the Imperial College London, and finally a Master of Business Administration, Banking, Corporate, Finance and Securities Law from AGSM UNSW.
(Continued on page 24)
ISSUE 113 | APR/MAY 2023
Meet the ZR - Low speed. High torque. Maximum performance. Visit a reference site | Book a trial | Request a free waste audit | info@focusenviro.com.au
PP: 100024538 ISSN 1837-5618
What now for soft plastic waste?
REDcycle founder Liz Kasell.
3-Stage Grinding Process
Provides Faster Reduction

Astec - Peterson's powerful up-turn 3-stage grinding process provides better fracturing of material and a more consistent product, giving you just the product your buyers are looking for.
The Impact Release System
Protects Your Investment
Astec - Peterson's patented Impact Release System's air bags provides uniform grinding and protection from contaminated feedstock, a feature unique to Astec - Peterson grinders.
The Impact Cushion System
The Second Line of Defence
Urethane cushions and shear pins help protect the mill from catastrophic damage in the event of a severe impact from contaminants in the feedstock.
Astec - Peterson offers horizontal grinders from 433-839 kW, offering grinding solutions with output at the lowest cost per ton. Visit us at www.astecindustries.com and see why we have been leading the industry for over 35 years!

www.komatsuforest.com.au
Land clearing, mulch, compost, asphalt shingle tiles, scrap wood, biomass, green waste-we can handle it am
2710D Horizontal Grinder
Portable 6 Efficient
Engine 433 kW or 570 kW
Length 1612 cm
Weight 30900 kg
Feed Opening 153 x 81 cm
5710D Horizontal Grinder
High Production with Consistent Sizing

Engine 722 kW
Length 1800 cm
Weight 42184 kg
Feed Opening 152 x 102 cm
Astec - Peterson is represented by Komatsu Forest in Australia and New Zealand, providing industry-leading product support and expertise.

6710D Horizontal Grinder
Largest Grinder with Highest Output
Engine 839 kW
Length 1860 cm
Weight 48987 kg
Feed Opening 168 x 127 cm
Komatsu Forest Pty Ltd.
11/4 Avenue of Ame ricas
Newington NSW 2127 Australia
T: +61 2 9647 3600
E: info.au@komatsuforest.com
Ltd
Komatsu Forest Pty
GENOX’S NEW SHREDDER IS A PLASTIC PIPE’S WORST NIGHTMARE. THAT’S APPLIED THINKING.
EPA olive branch
IT’S no secret that the waste/resource recovery sector and the various state and territories’ EPAs haven’t been too friendly towards each other over the years. The former is trying to make a buck while finding ways to repurpose or dispose of waste, while the latter is charged with protecting the environment from indiscretions carried out by everybody (not just the waste industry!).
That a multi-billion-dollar industry is frequently at loggerheads with a state government-appointed agency designed to keep its (largely) minor excesses in check is of no surprise, nor that they eye each other suspiciously with regards to their various motivations.
Which makes it even more interesting that when I (yet again) approached a media team at one of the state EPAs about having a yarn to the CEO, the answer was a pleasant ‘yes’. By the time this magazine is distributed NSW EPA CEO Tony Chappel will have been in the job for about 10 months. Like his predecessors he is unapologetic about the role the organisation plays in the state’s environmental landscape. Where he tends to differ from those that went before him is that he is open to conversations about being more collaborative in the space – whether talking about product stewardship schemes or trying to cut through the screeds of red tape that appear when putting forward plans for resource recovery infrastructure.
I found Chappel a breath of fresh air. He indicated he intends to be around the
Chief Operating Officer Christine Clancy christine.clancy@primecreative.com.au
Managing Editor Mike Wheeler mike.wheeler@primecreative.com.au
Business Development Manager Chelsea Daniel-Young chelsea.daniel@primecreative.com.au
job for some time, and expects to leave a mark that will make the agency more user friendly. Time will tell.

Also in this issue, we talk to REDCycle founder Liz Kasell. To say the past six months has been stressful for Kasell and her team is the mother of all understatements. A lot of media scrutiny (some of it fair, a large amount of it not), and trying to solve what appears to be an insurmountable issue, has taken its toll. However, through it all Kasell and her team have tried to find solutions, co-operate with the EPA, try and repair a fractured relationship with two of the country’s biggest retailers, and is still hellbent on keeping that best part of 10,000 tonnes of soft plastics out of landfill.
As I write this, news is not good for the scheme. Both Woolworths and Coles have taken albeit light jabs at the scheme, and those that have transported the bales of plastics want to get paid and might take legal action if the account is not credited. However, there are bigger problems in terms of having infrastructure in place that would take care of soft plastics. That is a story for another day, but one we will be covering in the near future.
Finally, the Coffs Harbour Waste Expo is just around the corner. It’s hard to believe it has almost been a year since the last one. We talk to actress turned environmentalist and now Planet Ark CEO Rebecca Gilling about the event, and her role as a keynote speaker on the circular economy.
Inside Waste is available by subscription from the publisher. The rights of refusal are reserved by the publisher
Articles
All articles submitted for publication become the property of the publisher. The Editor reserves the right to adjust any article to conform with the magazine format.
Genox’s new J-Series pipe shredder is specificially designed for HDPE plastic pipes.

With a unique multi-rotor design and long life counter knives, it quickly shreds different diameter and sized pipes. Like all Genox equipment it comes with the support and back up that only a true local machinery partner can provide.

Design Production Manager Michelle Weston michelle.weston@primecreative.com.au
Design Blake Storey, Kerry Pert, Tom Anderson
Client Success Manager Glenn Delaney glenn.delaney@primecreative.com.au

Head Office Prime Creative Pty Ltd 379 Docklands Drive Docklands VIC 3008 Australia p: +61 3 9690 8766 enquiries@primecreative.com.au www.insidewaste.com.au
Subscriptions +61 3 9690 8766 subscriptions@primecreative.com.au
Copyright Inside Waste is owned by Prime Creative Media and published by John Murphy. All material in Inside Waste is copyright and no part may be reproduced or copied in any form or by any means (graphic, electronic or mechanical including information and retrieval systems) without written permission of the publisher. The Editor welcomes contributions but reserves the right to accept or reject any material. While every effort has been made to ensure the accuracy of information, Prime Creative Media will not accept responsibility for errors or omissions or for any consequences arising from reliance on information published. The opinions expressed in Inside Waste are not necessarily the opinions of, or endorsed by the publisher unless otherwise stated.
Call: 03 9706 8066 Email: sales@appliedmachinery.com.au Visit: www.appliedmachinery.com.au or www.genoxmachinery.com.au
Editor’s Note // Daily news updates at www.insidewaste.com.au 4 INSIDEWASTE APRIL/MAY 2023













People talk about being in the “building game” but it’s no game, it’s serious business. And you need a serious truck to handle bigger payloads. Isuzu Ready-to-Work trucks can carry around a tonne more than a typical ute, most only requiring a standard car licence. So if you’re ready to get serious, head to isuzu.com.au or visit your nearest Isuzu Truck Dealer now. Warranty is subject to the conditions outlined in the IAL New Vehicle Warranty. For further information please visit isuzu.com.au or contact your local dealer. Features shown are available across Isuzu 4x2 Ready-to-Work models only. FSA/ISZS1405 READY-TO-WORK RANGE Playtime’s over.






































































































































Get clarity with Cooee



New taskforce for soft plastics
THE Soft Plastics Taskforce has released a Roadmap to Restart, outlining the steps needed to launch a new supermarket soft plastic collection scheme, and the current state of play in the Australian recycling industry.
The Taskforce, made up of supermarket retailers ALDI, Coles and Woolworths, has been tasked with developing an interim solution to restore community access to soft plastic recycling following the suspension of the REDcycle program. The roadmap is that start.

Under the current plan, an initial in-store collection pilot is anticipated to launch in select stores in late 2023 – provided that REDcycle’s existing soft plastic stockpiles can be cleared. The new roadmap program would then be gradually rolled out nationwide next year.
While the Taskforce is working to launch in-store collections urgently, it is constrained by Australia’s limited access to infrastructure to deal with the issue.
At present, it would not be possible to recycle the volume of household soft plastics collected in a supermarket program using domestic infrastructure.
Accordingly, the Taskforce has plotted out the projected gradual increase in Australian soft plastic recycling capacity over the next year, as new operators launch, and existing processors expand.
From late 2023, the Roadmap Taskforce will meet the newly available processing capacity with a staged re-introduction of in-store collections so that the volume of incoming household soft plastics does not exceed the amount that can be recycled.
A spokesperson for the roadmap Taskforce said, “For the vast majority of Australian households, the only avenue to recycle their soft plastic waste has been through the REDcycle bins available at Coles and Woolworths supermarkets.
“…The Taskforce will reintroduce soft plastic collections when it can be confident that it will be properly recycled. We owe it to consumers to get this right.
“The best way to accelerate nationwide access to soft plastic recycling is through continued
investment in recycling facilities to bring forward existing plans to expand domestic capacity.
“We thank the Department of Environment, the Minister for Environment and Water Tanya Plibersek, and industry for their support.
“We look forward to their continued contribution as we design this stepping stone towards a circular economy for soft plastic.”
The current timeline to launch an in-store collection pilot by late 2023 is contingent on the ability to clear REDcycle’s existing stockpiles of soft plastic, of which Cole and Woolworths have recently been granted. Should new domestic processing capacity be taken up by the estimated 12,000 tonnes of stockpiled material for at least a year, the recommencement of instore collections will be delayed.
Accordingly, Coles and Woolworths intend to work through options to export the stockpiles to trusted recycling facilities overseas with the necessary transparency, traceability and government approvals.
This would allow access to advanced recycling beyond Australia’s existing domestic capabilities.
Over the coming months, the Taskforce hopes to engage other retailers, e-commerce platforms and consumer brands that generate soft plastics to contribute to the development of the new in-store collection program.
Daily news updates at www.insidewaste.com.au 8 INSIDEWASTE APRIL/MAY 2023
Cooee intuitively captures real-time data, saving time and money with easy reporting via customisable dashboards. Accurate data drives good decisions, so you can check waste quantities and revenues at a glance, seamlessly manage tip passes and even work in off-line environments. Call us on 0447 393 363 or visit us at cooeedata.com We can help for small to medium landfills and transfer stations
Is your
News //
The new taskforce involves ALDI, Coles and Woolworths.
Trial could help solve litter crisis
ROBOTIC dogs and artificial intelligence could help Australia fasttrack to litter-free status. In a trial by Veolia, dog-botics have been trained to collect littered waste, like plastic, paper and glass, proving they could help humans to clean-up the state of the environment.
Walking the streets of Sydney’s Bondi Beach, two dog-botics, aptly named Scoop Doggy Dog and Clean-up, have successfully collected littered bottles and cans from the promenade, to be recycled instead of potentially ending up in the ocean.

The robotic dog technology uses mechanical manipulation and camera detection intelligence to produce a series of custom-trained actions. As part of the Veolia trial, the dogs were taught to recognise waste in the street, and act by picking it up and disposing of it safely out of the natural environment.
With the ability to carry up to 14
kilograms, and a battery life of over an hour, the dogs swiftly moved along the length of the beach before having to empty their buckets.
Richard Kirkman, Veolia’s Chief Operating Officer, said the health of our waterways and our ability to solve Australia’s litter crisis could rely on the adoption of robotic technology.
“In all parts of our lives we use digital technology to improve our livability and this can include litter,” he said.
The machines accurately detected and collected littered waste, making it a potential gamechanger for cleaning-up the environment.
“The robo-dogs can recognise just about any object we train them to do – like a sophisticated version of fetch, only it could help solve our litter crisis and protect our oceans at the same time,” he said.
Millions of tonnes of waste
REDUCE DOWNTIME. INCREASE PRODUCTIVITY.
Recycling Made Easy.
is estimated to enter Australia’s oceans every year. Kirkman said the technology could help reduce this number, however humans still need to play their part.
“It’s not always possible to avoid waste in society, so when it can’t be prevented, people need to be vigilant about making sure it goes in the right bin as the first step.
“Technology is a great way to help us collect litter, but it should
never be our only line of defense,” he said. “We already use optical sorting to better recycle materials, we have biogas and energy-fromwaste projects to help recover more, and we’re committed to trialling all options on the market, so we stay ahead of advancements and drive ecological transformation in Australia and New Zealand. The robotic dog litter collection trial unleashed some promising results.”
KIVERCO PS122 PICKING STATION
• 4 bay sorting - Recovers clean stone, wood, paper, plastics, card or other recyclable materials at the option of the operator

• Combines air separation, magnetic separation, and manual sorting in one compact unit


• Adjustable belt speed - 1200 mm wide picking belt adjustable to suit waste material and desired recovery required
• The hydraulic jack leg support offers rapid set-up and transport
Daily news updates at www.insidewaste.com.au APRIL/MAY 2023 INSIDEWASTE 9 // News
SALES | HIRE | SERVICE | PARTS 1800 182 888 | www.lincom.com.au | sales@lincom.com.au | OFFICE LOCATIONS | QLD | N QLD | HUNTER REGION | NSW | VIC | WA
Mechanical manipulation is just one of the technologies used by the robotic dogs to collect rubbish.
Design critical for circular targets
A NEW series of reports unveil a critical roadmap to transition Australia to a circular economy through design, to help businesses and industry make real environmental change. Commissioned by the Department of Climate Change, Energy, the Environment and Water, the ‘Enabling Design for Environmental Good’ reports were produced by experts in eco-design and sustainability from across research and industry to inform a coordinated approach by government and industry to transition Australia to a circular economy.
The recommendations highlight opportunities for Australia to use design to improve the sustainability of production processes, materials, products and business models across local industries, as well as the risks of not doing so.
Australia has a goal to transition to a circular economy by 2030, but RMIT project lead and Associate
Professor Simon Lockrey said Australia was still in the early stages of its circular economy journey. Countries such as The Netherlands, who are seven years into their transition, are already making progress within fashion, water and technology.
“We’re already seeing the impacts of climate change playing out now,” said Lockrey from RMIT’s School of Design. “It’s not just impacting the environment, it’s also impacting the global supply chain, causing delays and driving up costs.”
That is why the research team is calling for a central body run out of the federal government to coordinate Australia’s transition to a circular economy through design.
“This call for a new and coordinated approach to designing sustainable products and industries is not a nice-to-have, but an urgent necessity,” Lockrey said. “We need an approach that ties together the
interests of the federal, state and local governments, which will help businesses and industry work towards a common goal.”
Collaboration for real change
RMIT researchers led a consortium of experts with consultants from Arcadis Australia and One Planet Consulting to craft 10 recommendations to overhaul products made locally or allowed to be sold in Australia, and how we handle them during their lifespan, for four priority sectors – textiles, plastics, buildings and electronic goods.
“Australian industry sectors will become increasingly uncompetitive unless these recommended actions are taken to align with leading nations on better product design, sale and circularity,” said Helen Millicer, Churchill Fellow and Director of One Planet Consulting.”
VACANT
The importance of design
Arcadis Australia project lead Richard Collins said design was crucial to ensure materials, products and systems were environmentally and economically sustainable from the start of their lifecycle.
“Design contributes to up to 70 per cent of the environmental impacts of a product’s lifecycle,” he said. “For instance, before a building begins construction, design decisions made on what sort of materials are used, how it’s built, where the building will be positioned, and subsequently how it performs over its life, will determine the environmental and financial impact of the building. If poor choices are made, the building will have negative environmental impacts, and also cost more to run, maintain or upgrade. This is bigger than just construction – the same design principles need to be applied across textiles, electronics, plastics and more.”
WCRA is known to be the oldest industrially registered employer body representing waste & recycling organisations anywhere in the world. On 7th May 2023, WCRA will turn 75.
WCRA’s membership is representative of the bulk of the NSW and the ACT waste and recycling industry, and it is a very well-resourced, highly respected industry association.
We are seeking the services of a suitably experienced person (or persons) to fulfil the duties associated with this role. This will involve the following-:
• Reporting to the elected Executive
• Ensure compliance with relevant registered association legislation
• Supporting Members
• Maintaining relationships with Sponsors.
• Retention & growth of Membership & Sponsorship.
• Influence policy impacting the waste & recycling industry.
• Participating in industry working groups.
• Search for and apply for funding opportunities (and grants).
• Manage training offer (including cost, quality and possible delivery).
• Facilitate working groups of Members (C&D, Liquid/Hazardous, ACT, MRF, Scrap Metal, WHS)
• And manage staff, the office and oversee all aspects of the accounts.
Applicants should possess the following attributes, skills and experience -:
• Be self-motivated.
• Have the ability to work within a small office environment.
• Possess high level communication
and negotiation skills.
• Excellent report writing skills.
• Have an understanding of the waste and recycling sector.

Applications should visit WCRA’s website www.wcra.com.au and familiarise themselves with WCRA’s background, services and offerings, including the annual calendar of events and the detailed position description.
Remuneration (including employee or contractor arrangements), support and a structured hand-over will be discussed with short-listed candidates and agreed by the Executive with the successful candidate.
Please send applications including a signed covering letter and full CV by email, by COB on Wednesday 26 April 2023 to executive.director@wcra.com.au
Executive Director Waste Contractors & Recyclers Association of NSW (‘WCRA’)
Key strategic leadership role responsible for shaping the future of waste, recycling and resource recovery in NSW and the ACT
POSITION
Daily news updates at www.insidewaste.com.au 10 INSIDEWASTE APRIL/MAY 2023 News //
Microplastics and human health
AS millions of tonnes a year of microplastic waste mounts in marine environments, Flinders University scientists warn the ramifications to wildlife, food webs and human health are still little understood.
An Environmental Pollution review of how plastic waste and their associated chemicals impact marine food warns that the impact of this “omnipresent contamination” of marine environments is “not well understood”.
It can take hundreds of years for plastics to degrade, with synthetic byproducts breaking into ever smaller particles through hydrolosis of hydrocarbons by microbes and exposure to environmental conditions. These plastics of various sizes pose a substantial risk to life forms right down the food web, says Flinders University College of Science and Engineering PhD candidate Elise Tuuri, from the Plankton and Marine Microbiology
Lab at Flinders.
“This study highlights the complexity of microplastics as a pollutant and how this can lead to difficulties in determining accurate impacts to human health and local marine environments,” she said.
“We know that large plastic debris can directly result in the death of larger marine organisms, through entanglement, strangulation, choking and starvation through ingestion, while smaller organisms can filter the water and ingest smaller plastic debris.
“As well, from laboratory-based studies we know this affects sea animals’ feeding behaviour and reproductive outputs and can cause developmental anomalies, changes in gene expression, tissue inflammation and the inhibition of growth and development to both adults and their offspring.
“However, the impact of microand nano-plastics to marine

organisms in the environment are still relatively poorly understood and are considered a hidden threat.”

Microplastic is a complex contaminant due to the diversity in sizes, shapes, polymer compositions and chemical additives, which also could variously impact specific marine species. The researchers call for more research into plastic contamination and synthetic additives to understand and prevent further potential environmental and biological health problems.

“Marine microbes dictate the flow of energy and nutrients but we do not know how plastics and their associated leachates affect microbial life at the base of the marine food chain,” says co-author Professor Sophie Leterme, from the ARC ITTC for Biofilm Research and Innovation at Flinders University.
“Studies have found that plastic pollution has a direct impact on bacterial growth, protein production,
the acquisition effect of major primary producers phosphorous and nitrogen-fixing rates, photosynthesis and genome wide changes, so we need to understand what chemical additives do to macrophytes, phytoplankton, zooplankton and microbes in the sea.”
Daily news updates at www.insidewaste.com.au APRIL/MAY 2023 INSIDEWASTE 11 // News Thank you for once again voting us Australia’s best small consultancy. BESTSMALL CONSULTANCY Call 02 8541 6169 or email info@mraconsulting.com.au mraconsulting.com.au Contact our award-winning team today to find out what we can do for you.
Microplastics have an insidious effect on marine life’s feeding habits.






Recycling Re-made
Visy is innovating and investing to find better ways to recover, recycle and re-manufacture packaging from recyclable materials.
Re-manufactured into new packaging
Global leader in packaging and resource recovery
Recovered recyclable material
150+ operations across Australasia For
We take 512,000* tonnes of glass. We make 3.2 Billion* glass bottles and jars.

A better way for a better world
more information VISIT VISY.COM
* Includes recyclable materials used by Visy and provided to other recyclers in FY2022.
SA EPA release drafts of PFAS guidelines
THE SA Environment Protection Authority (EPA) has released for consultation two new PFAS-related guidelines.
Per- and poly-fluoroalkyl substances, known as PFAS, are manufactured chemicals. They have been used in a range of industrial and consumer products since the 1950s.
They are of concern around the world because they are not broken down in the environment and can bioaccumulate in food and travel through groundwater.
All Australian states and territories are dealing with legacy PFAS issues.
The substances have been found at low levels across of a range of land uses. This is the first time the SA EPA has provided formal guidelines for site suitability and the re-use of PFAS-contaminated waste soils. As part of the EPA’s PFAS management regulatory strategy, it

has released:
• Draft PFAS-contaminated waste disposal site suitability guideline.
• Draft PFAS in waste soils guideline.
Australia’s Environment

Ministers endorsed the first PFAS National Environmental Management Plan (NEMP) in January 2018. It provides governments with a consistent, practical, risk-based framework for the environmental regulation of PFAS-contaminated materials and sites.
The draft guidelines are consistent with the NEMP but provide guidance tailored to South Australian environmental legislation. The EPA hosted two digital information sessions – one on each draft guideline – and invited interested members of the community to join online. The draft guidelines and further information are available online.
Heavy duty floor topping & repair system for waste handling sites Call us for more information NO DOWNTIME FLOORING 02 8840 8888 enquiries@ascoatings.com.au | www.ascoatings.com.au > Leachate Resistant > Industrial Strength > High Impact Rating > Rapid Cure Times > Joint Repairs AS/NZS 4801 Daily news updates at www.insidewaste.com.au APRIL/MAY 2023 INSIDEWASTE 15 // News
PFAS has been found across a range of land uses in Australia.
Arking up for a circular economy






ONE of the keynote speakers at the upcoming Waste 2023 Conference at Coffs Harbour will be Planet Ark CEO Rebecca Gilling, whose topic will be A Carbon Neutral Circular Economy for Australia: Connecting the Dots. Getting to carbon neutrality is no easy task, but utilising the organisation’s three main planks, she thinks Australia can get there. Those three planks are carbon neutrality, circular economy and connecting people with nature.
“If we are going to achieve net zero emissions by 2050, about 55 per cent of those emissions can be dealt with by converting to renewable energy,” she said. “The remaining 45 per cent will be around how we use products and materials, as well as food and land. And we believe that it’s vitally important that people maintain that connection with nature, so that they understand what it is that we’re trying to protect.”
One of the issues to getting





















companies onboard are the costs involved. When mandated to look towards a circular economy, companies have to comply. But what about voluntary adherence?
“We did a research project surveying a number of businesses,” said Gilling. “Most said that they thought that the circular economy was going to be important to their business sometime in the near future. We know that businesses are focused on net zero emissions and that’s driven partly by a need to reduce costs with increasing costs of fossil fuels to their businesses. But it’s also being driven by consumers and shareholders who are demanding these sorts of changes.
“You talk about the costs to business, and that’s certainly one of the barriers that is perceived by business. But what we know from experience abroad is that the circular economy is a cost saving to










business because it directs energies further up the waste hierarchy, to avoid, reduce and reuse ahead of recycling and waste to landfill.”
Gilling said lack of collaboration is an issue. During a visit to Australia last year, former Dutch Environment Minister Jacqueline Cramer noted that businesses in Australia were less willing to collaborate than their European counterparts.

“That is going to be one of the challenges moving forward,” she said. Gilling pointed out that it’s also for individual businesses to look across their value chain and see how they can work not just to make their own business more sustainable but connect with a value chain to avoid loss lost value. According to Gilling, this is because every time there is waste in a system, there is lost value. That’s the point at which stakeholders need to recognise they’re losing value and ask how can they capture that value and keep it
back in the supply chain.
Moving forward, Gilling would like to see more procurement from entities. Whether that is at council/state government level, or businesses, she doesn’t care. There is demand from the public, but governments need a push.
“Government procurement is a great place to start. And certainly, we’re hearing the right noises from government about their own procurement policies,” she said. “It’s also about education – for businesses, government, and consumers to look for products that contain recycled content because that’s how you close the loop.
“It’s happening. As we’ve seen in roads, for example where they contain soft plastics and textiles and various other things. They’re a low value use, but at least it’s replacing virgin material, which is important.”
Gilling will be speaking on Tuesday 9th May.
Daily news updates at www.insidewaste.com.au 16 INSIDEWASTE APRIL/MAY 2023 News // Maximise Recovery... Reduce Landfill Costs Eriez.com.au | 03 8401 7400 through… Superior Equipment Innovation Service Support Testing Eriez equipment enables the recycling industry to maximise the recovery of mixed metals from comingled waste, in turn increasing product purity to achieve the highest value.
Return and Earn $900 million in refunds
NSW has reached a new recycling milestone with nine billion bottles, cans and drink cartons returned by the community through the Return and Earn return point network.
Danielle Smalley, CEO of Exchange for Change, scheme
James Dorney, CEO of network operator TOMRA Cleanaway, said we can all be proud of what we have achieved working together for a cleaner and more sustainable state.
coordinator

 for Return
for Return


and Earn said the community’s tremendous support for the scheme is delivering benefits to the environment and the people of NSW.
“While [the] milestone means thousands of tonnes of plastic, glass and aluminium has avoided ending up in litter or landfill, it also represents $900 million in container refunds back into the hands of the community,” she said.
“These funds are helping offset people’s weekly shopping costs, providing pocket money for kids and have become an important avenue for fundraising across the state, with more than $42 million raised for charities.”
When you combine the nine billion containers returned via the return point network together with kerbside recycled containers redeemed by local material recovery facilities, 11.73 billion bottles and cans have been collected since the scheme began in 2017.

This equates to 837,000 tonnes of materials recycled and a reduction in CO2 emissions equivalent to taking more than 400,000 cars off the road for a year.
“It’s humbling to know Return and Earn is having a positive and measurable impact,” he said.
“We have a proven record of success with 100 per cent of glass and plastic containers collected through the network reprocessed into new containers and other food-grade packaging right here in Australia.”

Up to 89 per cent of NSW residents support the scheme and 82 per cent have participated.
One example are siblings Isabella (15), Giovanni (14), Valentina (12) and Romario (10) Silva from Preston. NIcknamed the Bottle Kids for obvious reasons, they have been returning and earning with mum Collette since 2018.
So far, the family have collected 86,000 bottles and cans and hope to reach 100,000 by the end of the year.
“The kids like to encourage our neighbours to recycle too, and it’s great knowing we’re making a positive difference,” said Collette.
Return and Earn is delivered in partnership with Exchange for Change as scheme coordinator and TOMRA Cleanaway as network operator, and is funded by the beverage industry.





Daily news updates at www.insidewaste.com.au APRIL/MAY 2023 INSIDEWASTE 17 // News
25-26
The returning of more than nine million containers has been the equivalent of taking 400,000 cars of the road in terms of C02 emissions.
October 2023 Melbourne Convention & Exhibition Centre Exhibit in 2023
Over 200 Council and government department attendees visited Waste Expo Australia.
Australia’s largest gathering of waste management and resource recovery professionals.
100% of exhibitors say they were extremely satisfied with Waste Expo Australia in 2022.
AR-512476_WMR HP Ad_105x285mm.indd 1 3/2/23 6:53 PM
93% of exhibitors rated the quality of buyers as ‘good or excellent’ at Waste Expo Australia.
From the CEO’s desk
Are we destined to repeat the same mistakes?
targets for recycled content in packaging.
• Increasing Australia’s domestic recycling capacity.

• Increasing the demand for recycled products.

• Exploring opportunities to advance waste-to-energy and waste-to-biofuels.
phoenix. But like the mythical phoenix, its success remains fictitious. Instead, we have an incoherent document with inadequately planned actions, such as the waste export bans (a sound idea in theory but problematic in reality). Four years on, the National Waste Data Report reveals we have a massive infrastructure shortfall, 14 million tonnes to be exact. Throw in our abysmal 1.8 per cent improvement in resource recovery over the past four years and that’s 17 per cent below where we need to be, miles off hitting the 2030 targets.
•Updating the 2009 Waste Strategy by year end, which will include circular economy principles.

It is time to take stock and examine what has been achieved since these decisions were announced. Now, seven (7) months may not seem like a long time, however in that time we have seen further markets close (Malaysia, Indonesia, Vietnam) and if you are an operator under continued financial stress, seven (7) months could make or break you.
Add in other important 2030 goals, like the pledge to protect 30 per cent of land in line with the UN Convention on Biological Diversity, as well as achieve 43 per cent carbon mitigation, and you realise the common denominator to push Australia closer to these targets is our WARR sector. If we reduce the reliance on virgin materials and use our sector’s secondary raw materials, we can significantly reduce emissions and energy. Recycling glass alone reduces as much as 87 per cent carbon and 82 per cent energy.
Following the April MEM, we have had three (3) states step in with varying degrees of financial assistance for industry (councils and operators). This should be expected considering almost all states (except Queensland and Tasmania) have access to significant waste levy income each year. On the eastern seaboard, Victoria has approximately $600 million in waste levy reserves in the Sustainability Fund and NSW raises more than $700 million per annum from the waste levy. There is certainly no lack of funds that can be reinvested into our essential industry.
Despite our sector being critical to the success of Australia in achieving these targets –we still have not seen the necessary paradigm shift. Instead, we’re in a constant state of market failure at real risk of becoming a dumping ground for low value materials, with our essential sector continuing to be at the receiving end of cost and risk transfers from the rest of the supply chain.
Funding helps but as we know, the money goes a much longer way with Government support and leadership, as well as appropriate policy levers.
VICTORIA
We are on the cusp of another crisis, and instead of running towards it, we need our governments to turn their attention to developing a new economic model that recognises the shared responsibility of material management and importantly, the value of materials our industry produces, while correcting the balance, so that resource recovery is more cost effective than landfilling. Even if we do all of these, there’s one more missing piece that we need or nothing else will matter and we will never meet our 2030 targets – markets.
Victoria has arguably been the most active and earnest in supporting the industry post-China, with two (2) relief packages announced to support the recycling industry, valued at a total of $37 million. The Victorian Government has also gone above and beyond all others states by announcing it would take a leadership role in creating market demand for recycled products.

SOUTH AUSTRALIA
Market intervention by the government is not unheard of (export bans anyone?). But what has so far been ignored is that we operate in a global market. We are a significant importer, and we have, over the years, lost much of our domestic manufacturing base. Export bans can only work if we have local markets for the materials we now need to process here. If all these crises we’ve been through and the most recent war in Ukraine have taught us anything, it’s that we desperately need to build our resilience. So, in the immortalised (but
Government announced a $12.4 million support package comprising $2 million of additional expenditure, $5 million additional funding for a loan scheme, together with targeted funding from the Green Industries SA budget. The Government has also offered grants for recycling infrastructure.
NEW SOUTH WALES
At first glance, New South Wales’ eye-watering $47 million recycling support package was heralded as the spark of hope industry needed. However, on closer inspection, the bulk of this package that was funded via the Waste Less, Recycle More initiative and therefore the waste levy, was not new, making it very difficult for stakeholders, including local government, to utilise the funds as they were already committed to other activities. Some of the criteria proposed by the NSW EPA also made it challenging for industry to apply to these grants. On the plus side, efforts are being made by the NSW Government to stimulate demand for recycled content through the intergovernmental agency working groups that have been established, though no tangible increase in demand or facilities have developed… Yet.
QUEENSLAND
Unlike its neighbours, Queensland did not provide any financial support to
W
WMRR: Suite 4.08 | 57 St Johns Road | Glebe NSW 2037 | t: 02 8746 5000 | e: info@wmrr.asn.au | w: www.wmrr.asn.au Daily news updates at www.insidewaste.com.au 18 INSIDEWASTE APRIL/MAY 2023

AUSTRALIA’S NEW ONLINE PORTAL DEDICATED TO BUYING, SELLING AND HIRING WASTE AND RESOURCE RECOVERY EQUIPMENT. Whether it’s a skip loader, shredder, wash plant or excavator, this is your onestop-shop for buying, selling and hiring a variety of machinery and equipment from both dealers and private sellers. Advertise on Inside Waste Marketplace to reach the right buyer. For advertising opportunities, contact ben.coleman@primecreative.com.au or call 0466 545 664 BUY. SELL. HIRE. Scan the QR code to find out more. MARKETPL ACE



(Continued from front cover)

“AT the other end of the scheme were downstream processors and partners who were trying to scale up as quickly as they could, but there wasn’t the infrastructure available due to the supply chain problems caused by the pandemic. Parts were stuck on docks as shipping avenues dried up. It was complete paralysis. The only thing that wasn’t paralysed was consumer participation, which increased massively.”
red line WALKING THE THIN
Europe is delayed by nine months’.”
As mentioned, one of the issues that hasn’t been a good look for the organisation is the portrayal that it was surreptitiously stockpiling the plastics. Plastic continued to be delivered and recycled by processing partners, but there was more volume coming in than could be accepted at the time. Ironically, several processing partners were concerned that as capacity was re-established post-pandemic, there would not be enough plastic feedstock
Added to all this was the lack of procurement by end markets such as local councils to the companies creating the end products being made from the recycled soft plastics.




“Our processing partners told us, ‘council orders have been placed on hold because councils are diverting all those funds to other areas’,” Kasell said. “We were told by downstream partners like ‘We are sorry, can you hold deliveries? We’re not able to take what we committed to take. The new processing line that we ordered from
available to supply new higher throughput lines. REDcycle was asked to provide confirmation it would be an ongoing supply partner and could provide the necessary feedstock. This gave Kasell confidence that as the country emerged out of COVID, the soft plastic recovery system would be back in balance and in a position to grow.
Kasell expected the bales to be kept for a little while as end market demand began to free up once COVID had run its course. Then processor Closethe-Loop’s facility had a catastrophic
Daily news updates at www.insidewaste.com.au APRIL/MAY 2023 INSIDEWASTE 21 // Cover Story
“Then, due to people staying at home all day through COVID, those bins were filling 12 times a day, or 15 times a day. If you multiply that by over a thousand locations, you realise the volumes I am talking about.”
A bench made from recycled soft plastics.
fire and suddenly REDcycle’s most important recycling partner, was shut down for a minimum of 12 months. Call it overly optimistic or bullheaded, the one thing Kasell didn’t want was the stored plastic going to landfill. In a practical world, that is exactly what should have happened, said Kasell. However, the REDcycle team was working hard to make sure that didn’t happen. Even though REDcycle was under intense media scrutiny, as well as the watchful eye of the EPA, and the politicians who never miss an opportunity to make the most of a disaster, she was determined the plastic bales would processed into other products.
Kasell’s biggest enemy wasn’t the stored material, supermarkets, the media, government bodies, or even politicians. It was time . Again, she acknowledges that the stored plastic needed to be managed in compliant way. However, both the Victorian and NSW EPAs were under high-pressure scrutiny from both the public and their political masters to solve the problem as soon as possible. Then there was the recent revelation in a Sydney Morning Herald article that the company responsible for transporting the bales needed to be paid.
And it’s not as if REDcycle was not doing any forward planning. Kasell said that although there was very little redundancy built in, REDcycle had been running for many years and understood the consumer participation would increase – just not at the overwhelming rate it did. It went from collecting approximately 1500 tonnes of soft plastics to more than 7500 tonnes in just over two years. This dramatic increase could not have been predicted by REDcycle or any other industry organisation. There is still an estimated 350,000 tonnes of consumer soft plastic being placed in the Australian market each year, so REDcycle’s volume represented a very small fraction.
There is also an irony in the scheme falling over, because there is going to be a need for it, or a similar entity, in the near future, as acknowledged recently by the triarchy of supermarkets who are putting together their Roadmap to Restart – a supermarket-run soft plastics collection scheme. This is because there are companies that are going to need the feedstock to deliver outcomes such as turning the plastic back into oil to be reused in another capacity. And it won’t be a few thousand tonnes of feedstock that will be needed, but tens of thousands. Two companies already have either imported technology or about to

commission plants that will be capable of processing the plastics – APR Plastics and Licella. The latter will have the capacity – initially – to process 70,000 tonnes of product and will scale up to 120,000 tonnes. Not only will these processes give a new use to a product that would have been landfilled, but it will reduce the need for virgin plastics.
In June 2022, Inside Waste’s story, Softly Softly- the Troublesome Waste Stream of Soft Plastics, Replas then director, Mark Jacobsen is quoted that Replas processes about 3000 tonnes per year but has capacity for up to
10,000 with most of it coming from the aforementioned REDcycle Program.
Statements like these gave REDcycle the confidence that the capacity and end market constraints were temporary and well on the way to being unblocked.
“We used to cop a lot of blame for not having more locations and not having more retailers on board,” said Kasell. “That was a big criticism of REDcycle before this happened – that our network wasn’t big enough. We’d have at least 30 emails and comments every week about why we didn’t have locations here and there, and why we
weren’t bigger, and why we weren’t picking up more, why we didn’t have more bins? We only added a handful of trial locations over the past four years because we were trying to manage this system so carefully and responsibly.”
Another key to the scheme’s demise has been the lack of infrastructure and the lackadaisical approach by many in the industry to hit the reset button when it comes to soft plastics. As pointed out in Inside Waste’s February/March cover story written by wate consultant Justin Bonsey –“Two heartening trends to emerge from this somewhat histrionic media response and subsequent community outcry [over REDcycle’s stockpiling] have been an underlying devotion for soft plastic drop-off akin to that of a cultural institution, and that the rug of soft plastic complaisance has been

Daily news updates at www.insidewaste.com.au
22 INSIDEWASTE APRIL/MAY 2023 Cover Story //
“Ironically, several processing partners were concerned that as capacity was re-established post-pandemic, there would not be enough plastic feedstock available to supply new higher throughput lines.”
The first REDcycle collection bin.





Recognising excellence across the waste, resource recovery and recycling sectors. 2023 NOMINATIONS ARE NOW OPEN www.wasteawards.com.au/nominations To nominate visit 25 OCTOBER 2023 SPONSORS HELD IN CONJUNCTION WITH

Daily news updates at www.insidewaste.com.au 24 INSIDEWASTE APRIL/MAY 2023 Cover Story // Lack of processing infrastructure is a huge issue in the soft plastics recycling story.
pulled out from under us, leaving us squinting into the post-BAU glory of possibilities for a top-down strategically co-ordinated whole-of-value-chain approach. This has started to clear the way for bigger-picture thinking we desperately need to not just stop the bleeding but heal the wound”.
With that in mind, Kasell and her team have still been working hard to find a solution for the impasse.
“We’ve been working nonstop since the program paused,” she said. “I have reached out to many organisations about solutions, and many have reached out to us as well.
“This challenge has been a catalyst in a way; focusing much needed attention on this issue and connecting key stakeholders. REDcycle is close to announcing an important downstream processing opportunity for the legacy and future feedstock. It’s an onshore solution with a new technology partner.
“Over a decade ago, REDcycle took on a waste stream that no one wanted to touch and created a recovery pipeline where one didn’t exist with the collaboration of community, retail partners, brand partners, and recycling partners, and we are proud of what we have achieved .
How does Kasell feel about the supermarkets – Coles, Woolworths, and ALDI, who have recently put in place the aforementioned roadmap?
“During the pandemic, the supermarkets had so many other pressing issues happening around them – staff shortages, keeping basics on the shelves, as well as supply chain disruptions,” she said. “It was a different time, and we thought we would emerge out of this together, but the downstream and processing capacity couldn’t keep up.”
And what about the relationship now?
“I would say we’re working together,” she said. “REDcycle developed the stock movement and management plan, and destinations for the material. The supermarkets have offered to support the management of, and responsibility for, the stock to help ensure this material is successfully recycled and we are very grateful for this. We’re working together to execute that plan. It’s quite complex from a logistics perspective. REDcycle and our team are absolutely committed to doing everything possible to see this material recycled. And I’m unwavering in my belief that can happen, we just need the planned onshore processing capacity to come online between next 5 to 12 months. And I’m confident that it’s coming. There has just been a significant infrastructure lag.”
While some might wallow in their
plight, Kasell is far from finished in her fight against soft plastic waste. Is she disappointed? Yes. Has this been the toughest time of her life? Yes. Does she feel a victim of circumstance? To a certain degree. But she is still as passionate about making sure none of the stockpiled bales end up in landfill.
Even though the company is in liquidation, Kasell is still working on downstream solutions to make sure companies taking the stock. For example, SaveBoard, a company that has a processing facility located at Warragamba, southwest of Sydney, recently took in 20 tonnes of the stockpiled plastics. Not a lot, but it’s a start. And despite some reports, the various EPAs have been helpful in trying to make sure REDcycle is doing the right thing with regards to the excess plastics.
“I do want to say that EPA has been working with us,” she said. “I know that the mainstream media doesn’t portray it that way, but the EPA have been very helpful and collaborative in terms of providing information that we need and giving us time to get things in order.
“Also, one thing I need to correct is that no one was ordered to landfill anything. There were multiple options, including the successful reprocessing of the material and exporting with the correct licencing or exemptions. Onshore processing was the first priority, with landfill being the last resort if no other options were available. For me, my absolute commitment was to see this material recycled and that has not changed.”
Another point Kasell would make is that if the REDcycle program had been paused in the middle of the pandemic, the disruption would have been much greater. She says that in hindsight that’s probably what REDcycle should have done but the thought of thousands of tonnes of soft plastics going to landfill made her feel sick knowing that once there, it had little to no chance of ever becoming a resource. It is truly a waste. And even if it was able to be mined from landfill, the amount of energy needed to decontaminate it would make the exercise moot.
As for the future, there are many important learnings that will create a roadmap for better outcomes.
For example, Kasell is adamant that one of the critical elements for success is the need for soft plastic packaging to be designed so it is ready to be recycled – in other words ‘design for recycling’. Then there is the quality of the material.
“If we make sure that packaging entering the marketplace is of the highest quality for downstream processors, it will open up capacity, and in some cases, without needing to add infrastructure,” she said. “Organisations
“During the pandemic, the supermarkets had so many other pressing issues happening around them – staff shortages, keeping basics on the shelves, as well as supply chain disruptions.”
and processors that are already onshore will be able to utilise the post-consumer soft plastics stream as a feedstock where they can’t now because of the mixed laminate structure films, which are incredibly challenging to process.”

Kasell also thinks the work that APCO is doing transitioning the brand owners and the packaging producers to meet the new design guidelines is important. She said she knows it is a balancing act because packaging plays a role and it’s got to perform; preventing food waste, as well as keeping the product inside safe and protected.
“That’s work that I loved being a part of, but I think it’s hidden in terms of how important it is, to create better recycling outcomes at the end by introducing highly recyclable materials at the beginning that still function in their primary purpose ,” she said.
“The other part is the transition that leads to Australia’s extended producer responsibility.
“We’ve done a significant amount of modelling. Our model wasn’t funded well enough to cope with this unpredicted increase we saw. But having said that, it’s about having the building blocks of product stewardship already there. I think those are two critical factors if we’re going to see success in the soft plastics value chain in Australia. Creating a robust system designed for recycling is critical. And a transition to a more robust producer responsibility model is also critical.”
As for her own personal future in the industry, Kasell is not going anywhere. For a mother who more or less fell into the industry, the past 10 years have shown her that this is her calling. REDcycle’s demise may be a bitter pill to swallow, but it hasn’t diminished her passion of keeping landfills free of plastic waste that can be utilised as a resource.
“This is my life’s work. I’m as passionate about it and even though I’m sad right now – you’re catching me during a tough time – I’m unwavering in my commitment,” she said. “I am also completely and totally humbled by the engagement on the part of the Australian community. They are responsible for powering this pipeline; REDcycle just gave them the opportunity.”
APRIL/MAY 2023 INSIDEWASTE 25 Daily news updates at www.insidewaste.com.au // Cover Story
EPA focused on innovation and collaboration
(Continued from front cover) PREVIOUS roles to his current assignation included executive positions in the tumultuous energy sector working for the AEMO (Australian Energy Market Operator) and AGL Energy. Does he see any similarities in the roles?
“My career has been all about bringing business, policy and government together to create better outcomes,” he said. “That was the attraction of the EPA; that it’s a role that can help facilitate those outcomes and drive them. There was a lot of learning in the energy sector, which was transforming quickly to reach some big ambitions. That has been a useful lens to think about the transformation we need in recycling and waste.
“There’s some good synergy between those industries. For me, waste and energy are two parts of the broader puzzle about a sustainable economy that works for people and protects the environment.”
And while there are similarities between the industries, he acknowledges that the waste and resource recovery sector has its own challenges. It’s no secret that previous administrations who have run the EPA have been combative towards the industry – some would say over the top, while others believe that the industry has deserved the scrutiny. Whatever the case, Chappel hopes to foster a more collaborative environment including mutual respect. When at the AEMO he realised that although traditional regulatory boundaries were necessary, the industry would stay static – to the detriment of both the economy and society – if it didn’t start collaborating with all stakeholders. He sees the waste industry in the same light when it comes to the much-needed infrastructure and the red tape around it. However, the EPA still has a regulatory role to fulfil. Balancing the
two over the next few years will be the tightrope that Chappel walks as targets set by government impact on how the EPA does its business.
“Unless we can manage both successfully, we’re going to fail,” he said. “When I look at the EPA, I see a lot of the similar challenges [as I had in the energy sector]. In the waste industry, getting up to 80 per cent waste circularity is an issue, which is similar to the energy sector trying to get to zero carbon. We will always have a relationship with businesses –we regulate how they are or are not compliant. The community expects, and every minister expects us, to fulfil that role.
“There’s an equally important, much bigger potential role about how we collaborate to co-create the future settings to enable that shift. And in a time of significant transformation, you can only get that right if you’re harnessing the wisdom of the whole sector. We’ve got some very smart people here, but we can’t sit in an office alone and work out the answer. We can only properly get to the right settings if we try to understand what business needs; what different parts of the value
chain are seeing – the whole system. That’s not to say we’ll always be able to do what particular businesses would like us to do because they’ll have their own commercial lens. But, if we don’t at least understand, and have some empathy for the commercial realities, we’re not going to succeed.”
Infrastructure woes
A lack of infrastructure is one bugbear highlighted by the REDcycle scheme being postponed due to lack of facilities to process soft plastics. Then there is the case of the East Rockingham energy from waste facility that is soon to be commissioned in Western Australia. Plans for the plant were first mooted more than 10 years ago but got bogged down in red tape along the way. It’s a hot button topic, and one that Chappel is aware of in terms of the synergy needed to make sure that a circular economy is up and running. With that in mind, the independent report on the NSW Resource Recovery Framework authored by Dr Cathy Wilkinson had many recommendations, many of which stated that the EPA needed to make aspects of its regulations easier to navigate. Does Chappel think government departments responsible for such things, including the EPA, need to be more malleable?
“I think we need to be. This is part of the change that the EPA and government as a whole need to embark on,” he said. “Obviously, we have to regulate harmful things down, but we don’t want to shut the economy down – quite the opposite. We want to breathe new life into it.
“For us as an organisation, and working with our key stakeholders inside government like the planning department, one of our priorities is how do we enable innovation more readily? We’ve talked a bit about that with our response to the Wilkinson review of our own framework. We need a sandbox, or some other tool,
that lets us enable innovation. Because we’re not helping the community be sustainable and healthy and prosperous if we’re not enabling those [aspects of the industry].”
Getting among the industry

There are a lot of different pieces to the waste industry – collectors, MRFs, organics, recycling, product stewardship schemes, an array of associations –Chappel knows there is a lot to cover. Time is at a premium, but he appears to be in for the long haul.

“I’m trying to get out and visit facilities and meet with operators,” he said. “I’ve taken our executive out to Griffith where we toured a feedlot and abattoir. Last week, I was on the road with some colleagues from the Department of Primary Industry looking at timber mills and dairy farms down on the south coast… I’m on that journey of learning. And it’s probably going to take a few years before I really know all the players in all the different sectors that we connect to, but I’m always open to those conversations. I meet with industry virtually every day.”
The core of what the EPA does –making sure all industries within the borders of NSW don’t cause harm to the environment – is still Chappel’s priority. When it comes to juggling industry’s needs with community expectations, he is firm on what the EPA’s remit is and how it needs to be enforced.
“If a business isn’t taking its obligation seriously, we will come down on them,” he said. “My expectation of the industry is that compliance is not the standard to be met, it’s a baseline to be exceeded. All of these industries have challenges with social licence and the easiest way to destroy that is by not meeting their obligations at a minimum. Our obligation is to protect the community and the environment from harm. And we take that seriously.
Daily news updates at www.insidewaste.com.au 26 INSIDEWASTE APRIL/MAY 2023 Thought Leadership
NSW EPA Tony Chappel has been in the job for almost a year.
“What I’m saying is, there’s a new conversation we need to have, which is; how do we help those operators as they think about innovating and the things they want to do? How do we make it easier for them and take that into government? We do grants on infrastructure, but we also often make things very hard through the process.”
Wilkinson’s Report
Getting back to the Wilkinson’s recommendations, Chappel said the EPA is being transparent when it comes to instigating the proposals outlined in the report. He said the EPA deliberately shared the report with peer groups before it published its response. They did so to get industry feedback and understand gaps that others in the resource recovery might see.
“Now we’re moving forward to try and implement those recommendations one way or the other,” he said. “Hopefully that’s one data point the industry sees, and there’ll be others. Over time, I am very hopeful and confident that we will get to a position of deep mutual trust. That’s not to take away from the fact we’ll always have that regulatory construct around meeting standards, but that’s hopefully a much less significant part of our engagement over time.”
REDcycle
One trying issue during the initial phase of his appointment was the suspension of the REDcycle scheme. He concedes there is a difference between somebody deliberately stockpiling waste in warehouses with nefarious intentions, such as fly-by-nighters stockpiling tyres and then abandoning the stream having fleeced tyre retailers, and a scheme such as REDcycle. However, he says the EPA has a job to do, and they’ll do it.
“Our first duty is to the safety of the community,” he said. “Whatever the intention, if there’s an unacceptable risk of fire, or other toxic kind of pollution that flows from these things, then we have to act. For us, it’s not about the intention but the risk to the community. [The] REDcycle issue shows collectively the very significant market failure of the systems we’ve currently got to manage and recycle and deal with packaging waste. There are three things you need for any essential recycling service to succeed – the collection process, infrastructure, and markets. You’ve got to have all three of those.
He said that this is one of the problems small businesses often face when they’re doing something people love. Everyone wants a part of it, but they can’t scale up quickly enough. A lot of businesses fail for that reason. It’s
very hard to stay disciplined and say to your suppliers, ‘Sorry, I can’t take more’.
“REDcycle has gotten to where it has because of a series of failures,” he said. “And from our point of view, the industry that produces this material needs to be involved in contributing to solutions. And that includes the supermarkets who collected 98 per cent of it, and passed it through.

“It was a systemic failing. It is a significant market failure. Plastic is a wonderful material, but it’s devastating to the environment; it never breaks down, it only breaks up into small particles, which get reabsorbed into the food chain. It is a growing threat to all ecosystems, including human health. We need more rigorous solutions.”

Like a majority of those working in the resource recovery sector, Chappel sees landfilling as the last resort for problematic waste streams. He likes the idea of product stewardship schemes as long as they have proper governance. He said they could be transformational, but there needs to be a commercial element. He gave an example of the many container deposits schemes operating throughout the country. He believes one of the reasons more than nine billion containers have been returned in NSW since the scheme’s inception is the value chain it provides.
“There’s a lot of opportunity to leverage some of that type of infrastructure for some of these other challenges,” he said. “For example, we’ve been consulting on expanding the NSW scheme to recover more glass. Glass is a wonderful material as it’s infinitely recyclable if it’s kept in relatively pure strains. Plastic can’t be recycled any number of times, it’s got limits, but it’s also much more impactful on the environment.”
The future
What about a national EPA? Chappel didn’t want to be drawn too much on the idea and stated he liked the sound of it. However, with Australia being a Commonwealth, and the tyranny of distance between relatively small populations on such a large continent, he acknowledged the practicality of having state and territory administrations.
Finally, what if Tony Chappel was given carte blanche to do what he wanted in the waste space? What would be his wish list if he ruled the world? He laughs at the questions but does have a serious answer.
“It’s about a lot more joined up thinking across different priorities,” he said. That collaboration again.
“We’ve got to get to a net zero economy, but we need to get to a circular economy, too. How do we do those things together? I think from our point of view, I’d like to see us transform our literacy and understanding and commercial empathy for the different industry sectors. Waste is a great example where the solutions to these challenges come from the investment that those players make. How do we enable that and set the markets up in a way that is positive for all of that?
I’m thinking it’s when we’ve made a step change in our own thinking. Then I hope that we get to an economy that is working for everybody, because it’s keeping us safe, but it’s also providing great quality jobs and good infrastructure.
“It’s satisfying to be able to contribute to, and hopefully solve, some of these problems. It’s nice to have a job that lets me contribute in some way to part of that.”
Daily news updates at www.insidewaste.com.au APRIL/MAY 2023 INSIDEWASTE 27 // Thought Leadership
REDcycle’s stockpiled soft plastic bales have been a challenge for the EPA.
Wastewater is just one of the various waste streams where collaboration is important.
Squeezing the life out of wastewater

THROUGHOUT the diverse and cultural landscape of the resource recovery/waste industry many companies, individuals and academic institutions have been trying to find ways to make a dollar from recovering waste materials.
Whether it be tyres, soft plastics, metals or other streams, the common catchcry is “anything but landfill!”
With some waste streams – costs and government approval processes aside – there is an endgame. With organics it might be converting FOGO into compost; with soft plastics it can be repurposed into a number of products; while paper and cardboard have a plethora of uses. Wastewater, on the other hand, is a different beast. It’s messy, hard to get rid

of and can be a headache for developers, councils, and commercial companies.
9-11 May 2023
Register today to secure your place!
Don’t miss the industry’s leading waste management conference. Numbers are limited and spaces are filling fast.
• Learn from industry experts
• Network with like-minded waste professionals
• Visit the extensive indoor and outdoor exhibition
• Participate in the Equipment and Technology Expo
• Watch the live broadcasts in real time, or at a time convenient to you
Be inspired in a learning environment where you can tailor your own learning needs through:
• A four streamed program
• Concurrent panel discussions
• Interactive workshops
• 3 social events

Mark your diary and be a part of this industry leading event!
www.coffswasteconference.com.au
(02) 6583 8118 | 0474 629 908
With that in mind, scientists from the Australian National University (ANU) are looking at new ways of separating and extracting minerals, metals and nutrients from resource-rich wastewater. These scientists include Associate Professor Caitlin Byrt, and Doctors Annamaria De Rosa and Samantha McGaughey. Inside Waste spoke to Byrt about what they are trying to achieve. Navigating the intricacies and the science around how these materials can be recovered can be challenging, but if the team is successful, it could be at the forefront of a revolution that can tap an unlimited potential for minerals and metals.
Beginnings
Byrt and the rest of the team are plant biologists and have spent most of their careers researching the molecular mechanisms inside plant cell membranes that control what moves in and out of a plant’s system – this can include water, nutrients, metabolites, metals, minerals and signalling molecules. Then there are the proteins inside the cell membrane.
“Every single living cell has a cell membrane – a lipid membrane,” said Byrt. “Inside the membrane, you’ve got proteins. And some of these proteins e what we call selective membrane transport proteins – they only let certain things pass in and out of the cell.”
Byrt gives an analogy of going through airport security to explain the process. Some things are allowed through while others aren’t. In the case of molecules, these proteins might recognise a sodium molecule and allow it into the inner sanctum of the cell, while it might not be so accommodating to a lithium molecule that might be trying
“It is basically doing a three-
dimensional pat-down to identify what each different molecule is, and then either let it through or not,” she said. “We study the protein structure, their function, how they work. We want to know how the selectivity works. Why do they let through one type of molecule but not another?”
Byrt and the rest of the team didn’t start out trying to separate materials from wastewater. Their first foray into this type of research started with trying to improve crop yields – wheat in particular. The grains industry needed crops to be more salt tolerant due to the salinity of the soil in many agricultural areas.
“We found some wild wheats that had adapted to salty soils,” she said. “They had this molecular mechanism that helps them to push the sodium out of the key plant tissues so that it didn’t build up as much in the leaves. The mechanisms could restrict sodium building up in the transpiration stream that was going up to the leaves, which helped to ensure that the plant could maintain enough potassium in the leaves.
“Potassium is a critical nutrient for plants. The plant tries to accumulate the potassium, but it knows that sodium will try and get in at the same time. There are mechanisms are in place that stop too much sodium from accumulating in the transpiration stream, so that it doesn’t build up in the leaves.”
Having found this out, the trick was to try and mimic that principle so that they can create a mechanism that will help extract the aforementioned minerals, metals etc from wastewater. Luckily for the team, this was a reference point from which they could garner information.
The word “Aquaporin” is not only the name of a type of protein but also the name of a Danish company that worked with NASA to try and solve an important problem – how to make sure the recycled
Daily news updates at www.insidewaste.com.au 28 INSIDEWASTE APRIL/MAY 2023 Wastewater //
Plant cell membranes could be the answer to retrieving minerals from wastewater.
COVE RESORT
Harbour
OPAL
Coffs
water is as pure as possible for the astronauts at the International Space Station (ISS).
Because water is a heavy substance, it makes sense that most of the water transported into space needs to be recycled, so that there is less stress on the payload when moving supplies up to the ISS. The water filters Aquaporin built manage to recycle clean water from approximately 94 per cent of the wastewater. The cutting-edge Aquaporin filters replaced old size-exclusion filters that were originally used in space, which were not up to the task and would sometimes get clogged. This in turn meant contaminants would get through and the astronauts would become sick.
“The team developing the aquaporin filters thought, ‘Okay, what happens in nature? How does nature separate a water molecule from all the other stuff to get pure water?’” said Byrt. “They got interested in the aquaporin mechanisms because this is what living cells use to filter water.”
Aquaporin molecules are in all different forms of life. Humans have 13 of them in their body. They help with kidney function and hydration. The company “borrowed” the aquaporin mechanisms and installed them into a filter, which is now used in the ISS to produce water to a much higher purity. They are also
adapting these filters for other areas including fabric dyeing factories and even PFAS removal.
“They’ve many important applications where they specifically remove water from complex mixtures” said Byrt. “Which means that if you have a wastewater, such as from fisheries or wastewater from the agricultural industry – where there is a lot of nutrient-rich dissolved molecules – if you process it using this type of technology, you can pull the clean water out and reuse it, but all the other things in the waste still remain undifferentiated. And they end up as waste.”
It was after looking into this technology that the team knew what they had to do – study the different types of proteins from plants that separate out nutrients. They just didn’t want to pull out water molecules, but target specific nutrients, metals, and minerals.
“The idea is to borrow those mechanisms, and then we instal those mechanisms into a membrane technology,” said Byrt. “Then you input complex wastewater and pull out particular target resources on the journey. But naturally we still also want to harvest the clean water at the other end.”
What the team has achieved so far is
the use of lab-based systems to test the function of candidate proteins. Their next challenge over the next three years is to go from lab experiments to an actual box that they can take to an industry site. They received some funding at the end of 2022 to help them try and achieve that goal. However, will it be financially viable?


“That’s a good question,” said Byrt. “What the companies that have developed the water extracting systems have demonstrated is that there’s a huge market demand for pulling the clean water out. If we had the infrastructure where industrial wastewater was already being processed to separate out water, then I imagine it wouldn’t be too big a leap to add in the additional modules that can separate out other target resources.”
Practicalities
Theories are great, but there also has to be a practical side to how these actions will be carried out. Byrt sees a range of answers, but none of them will be easy. For example, there are University of Queensland researchers who have been progressing trials utilising plants called hyperaccumulators to harvest resources. The process is called phytomining, or agromining, which is a method of extracting metals from these plants.
They thrive in metal-rich soils where other plants cannot survive.
“There’s some plants that can accumulate up to 17 per cent nickel in membrane bound compartments, so you can use this material to pull that nickel out,” said Byrt. “It’s a win-win situation because it’s also helping fix atmospheric carbon issues. This is because plants grow, use the energy from the sun and pull carbon dioxide out of the atmosphere, and then they’re doing this other resource processing service for you at the same time.”
However, what about plants that can’t survive under such conditions? Byrt and the team want to build a system that will carry out a similar function. Byrt knows that this problem of toxic waste is an issue. She said that if you put mine tailing waste on any sort of living organism, you’re most likely going to kill it. Currently, any type of man-made system is costly.
“When it comes to mine tailings and things like that, sometimes we hear that, ‘there’s $2 million of value in the waste but $4 million of headaches’,” she said. “What we are working towards is learning from the selective separation systems inside plants that enable us to do it on a small scale. We borrow their function, and then we work towards manufacturing that into a technology
Daily news updates at www.insidewaste.com.au APRIL/MAY 2023 INSIDEWASTE 29 // Wastewater
Dr Annamaria De Rosa at her lab at ANU.
Harvesting metals from wastewater so they can be reused is not just a pipe dream.
Wastewater //
that we can apply in conditions where a living cell cannot be used. We are trying to create a system that will mimic what a plant does for dealing with problem wastes.”
On what products can it be used? Wastes from batteries are just one example, said Byrt.
“When you take your old, dead lithium-ion phosphorus batteries and are about to throw them away, people ask, ‘how can we get the lithium back out of those?’” said Byrt. “If you could crush it up, and somehow get the components into a solubilised mess, then you would be more likely to be able to pull the target resources out.”
Byrt and the team know what the technology needs to achieve but getting it to a stage where it can be a working model is another story.
“With water filtration technology there’s all these different filters, but most filters just use size exclusion as the filtering process,” she said. “They don’t recognise a molecule. The key to the technology development is to figure out which parts from plants do the molecular recognition part. For example: ‘that’s a sodium molecule, that’s a lithium molecule’ etcetera.”
To get the system up and running, Byrt says you don’t even have to create an artificial prototype, nature can help build the parts.
“We don’t have to build them synthetically, because you can program
simple bacterial cells to build the parts for you,” she said. “You can take an E.coli bacteria and say, ‘okay, E coli, see that lithium transport protein that is coded for by this organism? I’m going to give you the program that is needed to build that protein, and you can make a whole pile of it, and I’m going to harvest it, and then I’m going to embed it in a membrane and put it in a technology, and then we’re going to test that technology and make sure it can do what we want it to do’.”
And, getting back to the commercial viability? As mentioned, the technology
is already out there in terms of filtering water, it’s just a case of adding more modules for more separation applications.
“If a company has already bought a system where they’re planning to recycle 80 to 90 per cent of their wastewater, and then you’re just adding on one little step to pull out something else, that makes economic sense,” Byrt said.
The team has two different threeyear projects on the go with regards to the technology – one is in the agricultural industry and aimed at nutrients, the other is in collaboration
with mining industry colleagues and focusses on precious metals.
“Over the next three years, our goal is to do trials in systems that are much closer to real life systems instead of our lab systems,” said Byrt.

And once those trials have been completed, the commercial reality will be apparent, or not, according to Byrt. Both her and the team are optimistic that a system can be found to make sure that the waste lost in water will be miniscule, and that metals and other materials can be harvested for reuse.

Daily news updates at www.insidewaste.com.au 30 INSIDEWASTE APRIL/MAY 2023
Associate Professor Caitlin Byrt said this technology could be a boon to the wastewater industry.
Dr Samantha McGaughey conducting an experiment in her lab.
The impacts of the energy from waste regulations
By Tony Khoury
THE NSW Government has enacted a prohibition on energy from waste (EfW) in NSW including Sydney, except in four specific locations across rural NSW.
These absurd regulations will lead to the loading of thousands of tonnes of waste onto trains or by large trucks within Sydney to travel hundreds of kilometres to a designated rural location, rather than building EfW facilities closer to where the waste is generated.
These regulations do not take a holistic view of the issues around sustainable residual waste disposal.
We call on political leaders to consider the long-term need for better environmental solutions by committing to re-visit these regulations.
The lack of waste disposal infrastructure within the Sydney metropolitan basin is at crisis level, as seen throughout 2022, (and several times in early 2023).
This is due to regulatory uncertainty affecting investor confidence in further development of the required, highly capital-intensive infrastructure. These
EfW regulations have resulted in an estimated $2 billion of proposed capital investment in waste disposal infrastructure to be put on hold, because projects are no longer allowed.

One of our members stated to WCRA, “we have spent millions of dollars on planning for a facility to provide an efficient, modern, and environmentally sound EfW solution for NSW. With these new regulations, we have shifted our priority to other states where there is a greater certainty that projects will occur”.
In late 2022 , the WCRA engaged The Centre for International Economics (CIE) to undertake a review of the economic and environmental impacts of the changes to NSW energy-from-waste regulations.
The report from The CIE concluded that introducing these regulations did not meet the requirements of the NSW Government’s own better regulation principles.
It is not clear what the basis for the regulation is, and why the preferred options have been selected. The report states as follows -:
There is no evidence of the problem identified by the government (that is, the potential oversupply of energy from waste facilities). In fact, the NSW Government’s Waste and Sustainable Materials Strategy indicated that NSW is running out of space to deal with residual waste and critical residual waste infrastructure is urgently needed.
• The regulations negatively impact the environment as they force EfW facilities to be located further from where waste is generated, with higher transport costs including the social and environmental costs associated with long-distance transport. This includes the unnecessary consumption of diesel, the risk of accidents and the impacts on road and rail networks.
The costs of transporting waste further from where it is generated are likely to far exceed the benefits of air pollution occurring in less densely populated areas. The NSW EPA has noted that EfW facilities in NSW are already subject to the most rigorous environmental controls in the world.
The regulatory changes enacted for EfW violate the intergovernmental
agreement on competition and productivity signed by the NSW Government in 2016. The changes are a clear restriction on competition and show no evidence that the benefits outweigh the costs or that the objective could not be achieved without restricting competition. Selecting specific rural locations benefits those businesses that own these locations and does not allow for businesses to find locations that optimise on commercial costs, while accounting for the other noncommercial criteria relevant to the NSW community.
Options not considered that would better meet objectives include building any relevant additional criteria into the assessment processes for proposals. This would ensure that any proposal that meets identified criteria can proceed rather than restricting EfW to specific locations.
The restriction on EfW locations is at odds with international experience. In other countries, EfW facilities are located in closer proximity to where waste is generated, with impacts regulated through air pollution controls.
Daily news updates at www.insidewaste.com.au APRIL/MAY 2023 INSIDEWASTE 31 // Energy From Waste
Transport costs and other environmental costs will impact negatively on the environment if energy from waste facilities are built far from where the waste is collected.
Waste myths series number 3: Landfill levies don’t work
By Mike Ritchie
WASTE is like a river that flows downhill to the cheapest price. If the cheapest option is landfill, then that is where it is going.
Some people like to say that waste is not “waste” but a resource. True in the sense of material resources but not in terms of economics.
Waste, by definition, is unwanted in the mind of the generator. That is how waste is defined in most legislation. It means, in practical terms, that the owner wants to get rid of it at the least cost possible.
It has negative value. The owner will pay someone to take it away.
If the owner was paid for it, we would call it a second-hand good. It would be for sale on Gumtree or eBay.
Economics (or inherent value) is the difference between waste and secondhand goods. Self-evident?
Think old furniture. If it can be reused, it is most often sold on eBay for a price and the buyer comes and picks it up.
Compare that to broken, old furniture. No value. In fact, negative value. The owner pays a waste company to come and take it away.
That waste company will try to dispose of it in the cheapest way possible. And if that is a landfill, that is where it is going.
It doesn’t matter that it contains
reusable wood or metal or hinges etc, when the overall cost to recover those materials – collection, labour, sorting – is more than the materials are worth, it is waste.
So, ‘What is waste?’ is, by definition, an economic question.
And therefore, if we’re going to fix our waste problem, we need to start with the economics in mind.
Waste will go to the cheapest option. If we can make the cheapest
option recycling, then it will go there. If it is landfill, it will go to landfill. Simple.
And that dear reader, brings us to the landfill levy.
Landfill levies push up the relative cost of landfill to reflect its unpriced externalities (odour, noise, traffic, resource depletion, greenhouse gas emissions etc) and to drive behaviour change.
They achieve the latter by making the relative cost of landfilling higher
than the relative cost of recycling.
Suddenly, recycling is a viable economic solution for disposal of ‘waste’. And it works.
Levies are the most important recycling and circular economy tool in the current toolbox.
The graph above clearly shows that the per capita waste to landfill has decreased in direct proportion to the rise in State landfill levies. There is noise in the data and a lag between rising levies and behaviour change due, I believe, to the delay in getting sorting and processing infrastructure approved and built.

MRA has analysed the regression analysis between state recovery rates and landfill levies and shown that 70 per cent of the growth in recycling in Australia in the last 20 years can be explained by the rise in landfill levies.

Another startling piece of evidence of the power of levies was the Queensland levy debacle. In 2013, the then Newman State Government removed the existing $35/t landfill levy and unwittingly created an arbitrage opportunity for Sydney waste.
Approximately 1.4 million tonnes/year of NSW waste was transported by truck and train from Sydney to Brisbane to take advantage of the suddenly cheaper landfill disposal options.
That river of waste was only plugged when the current government re-introduced a levy, at $75/t this time.
Daily news updates at www.insidewaste.com.au 32 INSIDEWASTE APRIL/MAY 2023 Landfill levies //
Landfill levies push up the relative cost of landfill to reflect its unpriced externalities.
The flood has fallen to a trickle.
No other policy instrument has had the effect that Australia’s landfill levies have. Of course, it would be remiss of me not to say that regulations or outright bans on landfill would be equally, if not more effective. But state governments have so far shown little appetite for bans to landfill. EPR systems also work but so far they have been limited to specific small waste streams such as mobile phones, drink containers or TVs. Similarly, no government has yet introduced economy wide taxes on virgin material use or tax subsidies for the use of recycled content in new materials. So, the levies remain our best current approach.
How high should the levies be?
Australia has a weighted average landfill levy of $105/t and with that we recycle 60 per cent of waste materials. Clearly to get to 80 per cent (the agreed national target by 2030) we need to ramp up policies and regulation.
There is no ‘right’ landfill levy value, but we know it needs to be higher than the current levels to drive an uplift in recycling. It needs to be high enough to drive the behaviour change we need. At this time, that is to achieve an 80 per cent diversion from landfill by 2030.
I have suggested that we start lifting levies towards a national uniform
levy $200/t. We can observe the rate of behaviour change on the way and tweak the policy on the go.
I suggest every government lift the levy by $4-10/t above CPI per year for several years. That will get us there quickly.

I also suggest that 100 per cent of the increases on current levy value be hypothecated to waste/recycling and local government infrastructure
and services. This would drive a strong positive feedback loop between increases in the levy and increases in recycling services.
My final point on the levy is to respond to the criticism that a levy is yet another tax. Yes, it is. It is a tax on landfill, and it is a worthy (and progressive) tax. We know that price signals work.
I would also suggest that state
governments use this mechanism as a way to progressively wean themselves off pokie taxes, stamp duty or payroll tax. If we are going to pay tax, let’s at least pay a tax that delivers jobs and other positive outcomes for society and the environment.
Landfill levies work. We need to keep going if we are to have any chance of achieving the national waste targets.

Daily news updates at www.insidewaste.com.au APRIL/MAY 2023 INSIDEWASTE 33 // Landfill levies
The higher cost for landfilling waste, the less waste ends up in the ground.
Training mushrooms to deal with waste woes
WHAT happens when an environmental charity meets a social enterprise to tackle one of the world’s most problematic waste products? You get a patented strain of fungi that has been trained to eat discarded cigarette filters.
Australian charity, No More Butts, and Melbourne-based mycologist, Fungi Solutions, have again joined forces to advance trials of the cigarette-fungi process that could see plastic cigarette filters recycled on a wide scale into products such as packaging materials or insulation panels, replacing another problematic waste stream – polystyrene.
Following various trials of the cigarette-fungi process over the past two years using butts collected in Perth, Cairns and Wollongong, No More Butts is now launching the CigCycle program to explore whether cigarette butt waste has a value.
The program involves diverting cigarette butt waste from landfill to use as a training substrate for mycelium. Or simply put, making cigarette filter waste a desirable food source for mushrooms.
According to No More Butts, approximately 4.5 trillion cigarette butts are discarded as litter worldwide every year, with Australia contributing around 8.9 billion butts to this figure, or around a third of the total number of cigarettes consumed.
No More Butts founder, Shannon Mead noted that while people often focused on cigarette butts being littered into the environment, it was important for them to also understand the impact cigarette butts had after they ended up in landfill.
“Cigarette butts are a big issue,” explained Mead.


“Even when people do the right thing and dispose of their cigarette butts the correct way, once they hit the waste stream and end up in landfill, they begin leaching damaging pollutants like arsenic and lead into waterways and soil systems.
“It takes about 15 years for plastic cigarette filters to break down. Through the CigCycle program we want to divert this plastic waste from landfill and recover the resource.”
The new recycling economy?
Myco-cycling addresses some of the world’s hardest to treat toxic elements created from plastics and petrochemicals by transforming waste into new materials via the process of mycelium-based bioremediation.
Scientists around the world are discovering many environmental uses for fungi, including their ability to break down complex carbons in the natural world and eliminate a significant strain on the ecosystem by diverting materials from landfills, allowing reuse into other applications. This process is both cost-effective and sustainable. Once remediated, the result is a renewable by-product that can be manufactured into new products, ultimately creating a closed-loop economy. Australia’s own Fungi Solutions’ myco-cycling model is a world-first in the way it approaches circularity of waste and its pioneering approaches to pollutant remediation. Its work aligns closely with United Nations’ Sustainable Development Goal 12 – Responsible Consumption and Production – by providing a circular economy framework for diversion of organic resources from landfill to produce sustainable alternatives to single-use plastics that are fully home compostable. The circular myco-cycling model can be established wherever there is waste, requiring just 12 per cent of the energy for plastic production, with 90 per cent fewer carbon emissions to create regenerative materials that nourish the soil after use.
Mushroom meets butt
Following initial trials in 2021, Fungi Solutions observed that mushrooms could be trained to digest plastic. In the environment; fungi naturally encounter the plant component cellulose. Fungi Solutions has worked to adapt that same fungus, teaching it to digest cellulose’s synthetic cousin – the plastic known as cellulose acetate.
Fungi Solutions Founder and Head of Research & Development, Amanda Morgan, explained that fungi systems are composed of branching mycelium threads that spread gradually over the cigarette butts, while digesting cellulose acetate. The key is convincing oyster mushrooms that cigarette butts are edible.
“Fortunately, training mushrooms to digest a cigarette butt is like training a baby to eat,” explained Morgan.
“The fungi systems dismantle some toxic components in the butts and render them non-toxic. The only components that remain undigested are heavy metals such as zinc, copper and lead.
“We are continuing research on possible methods of harvesting and utilising these metals in the quest for a perfect circular system. This would ensure that the remaining by-product of the mycelium and cigarette butt process is clean and entirely reusable.”
The fungi begin their digestive process by putting out fine webs of mycelium, with the roots spreading through the cigarette butt.
“It will branch out like a web and over time, you will see dirty butts become white mycelium as it expands trough the material to begin its digestion,” explained Morgan.
“Mushrooms excrete digestive enzymes as they move through places and break down food sources externally before bringing the nutrients into their systems.
“It’s a fascinating process to see, and since most of our stuff is grown in glass, we get to observe it.”
Daily news updates at www.insidewaste.com.au 34 INSIDEWASTE APRIL/MAY 2023 Litter //
Even when disposed of properly, cigarette butts can still be a hazard to the environment.
Photo credit: Emily Medbury.
At the end of the process, the mushrooms will have eaten the microplastics in the cigarette butts’ filters, leaving behind a material that can be used to create other products, such as boxes to collect cigarette butts.

Next steps
Buoyed by the success of the initial trials with Fungi Solutions, No More Butts are now launching an innovative program – CigCycle.
Supported by the Circular Economy Communities Fund delivered by
Sustainability Victoria under the Victorian Government’s circular economy plan, Recycling Victoria: a new economy, and in partnership with City of Melbourne, CigCycle targets Melbourne businesses wanting to bolster their sustainability credentials by disposing of their collected cigarette butt waste in a more value-added manner.
Mead hopes that through this program, businesses can assist in investigating potential uses for endof-life cigarette butts, as well as make
smokers pause long enough to consider what their cigarette butt does to the environment.
“In this free trial, we are calling on businesses that already collect cigarette butts as part of their daily operations, to collect them for us,” explained Mead.

“Program participants will be provided with all of the information and equipment necessary to ensure a limited change to existing processes.”
Morgan explained that the science behind the project shows that the process becomes more
effective with each generation of mushrooms cultivated.
“Our research with No More Butts looks into the efficacy of this process and if there are any opportunities to produce a material by-product from the recycling of the butts,” said Morgan.
“Fungi Solutions is excited to be partnering with No More Butts and the City of Melbourne to create opportunities for local venues to join us in tackling the issue of cigarette waste.
“By establishing a circular collection program and diverting these materials from landfill, we can invest in remediating this toxic pollutant and creating a cleaner world.”
With more than 450 tonnes of cigarette butt waste ending up in Victorian landfill each year – making up 11 per cent of all litter in 2021 – for many years, City of Melbourne has invested in preventing cigarette butts entering the environment.
In 2017, the Council collected more than 200,000 cigarette butts each week from 367 cigarette butt bins across the city – litter that may otherwise end up being washed down drains and into the Yarra River.
Melbourne-based businesses interested in taking part in the program can register at cigcycle.com.au
Daily news updates at www.insidewaste.com.au APRIL/MAY 2023 INSIDEWASTE 35 // Litter
Cigarette butts contain cellulose acetate, which mushrooms can feed on while breaking down microplastics.
Mushrooms put out a thin white fibre called mycelium, which covers a cigarette butt and breaks it down while drawing nutrients from it.
Photo credit: Emily Medbury.
Photo credit: Emily Medbury.


A one-stop, online resource centre for customers of commercial compost made from recycled organics
Find out more circularag.com.au/compost
Cool Compost
The main issue with FOGO
By John McKew
AS the national executive officer for the Australian Organics Recycling Association (AORA), I am on record as stating that one of the biggest issues facing the Australian organics recycling industry is contamination, contamination, and contamination.

With the continued rollout of FOGO across the country via multiple local government jurisdictions, contamination seems likely to remain an issue for a considerable time to come. The only solution is for all parties to tackle contamination together.

The AORA Vision 2031 Roadmap clearly articulates this – “The supply of quality feedstock to the processor gate is a key – in many ways, the key – component of the organics recycling supply chain. Clean, source-separated feedstock without plastics, chemicals and other contaminants is central to the growth of organics recycling rates”.
The Roadmap continues, “The single greatest issue facing the industry is the contamination of feedstocks, overwhelmed by plastics. Other contamination includes glass, metals, treated timbers, and persistent chemicals, which do not readily break
down in the composting process (or in nature)”.
The introduction of FOGO, while considered an important contributor to increasing the diversion of organics away from landfill, is unfortunately presenting itself as a major contaminant source.

There are most likely many reasons for this, including:
• A generation of community members who have become accustomed to comingling their waste streams especially when one bin (or maybe two) was all that was available.
• Consequently, FOGO is a new service for many households who need time to adjust and learn/be educated what can and what cannot be included in FOGO.
• A lack of understanding/awareness of the ‘why’ this is important and the consequences, for getting it both right and wrong!
“While testing and processing technology can address a fraction of the contamination problem, it is expensive and does not necessarily remove all of the contaminants consistently. Contaminated feedstock leading to contaminated products is anathema to the industry and would quickly destroy community trust in the industry and its products”, the
AORA Vision 2031 Roadmap notes.
Governments across all three levels (national, state, and local) have an important role to play in this. They develop waste strategies and are a regulator of the process and the feedstock. They are a controller of the collection process (especially local government). They are a customer of waste collection companies as well as a feedstock supplier, and they can be a significant end-user of organic composted products.
There are a number of states and local government jurisdictions working on the FOGO contamination issue. Feedstock contamination in any form is a problem and we know FOGO has exacerbated the contamination issue. This is resulting in increased costs to organic processors as they try to decontaminate FOGO feedstock (an almost impossible task) or, where the problem is too big to manage, covering the costs associated with sending the feedstock or the contaminated components back to landfill.
There is an understanding and appreciation that we are in an evolutionary phase of managing contamination across the recycling industries and there are
positive trends, including:
• The beginning of the phase out of single-use plastics in some states.
• Increased community awareness of the problems of contamination and a greater desire to ensure we recycle more of what we buy and use.
• Various education programs are being conducted by states and local government jurisdictions on what is appropriate to include/exclude in the various household collection bins.
• Greater awareness of the impact of a variety of persistent chemicals (e.g., PFAS) and how we can improve the management of these including the potential to phase-out use.
But more needs to be done, more consistently and more quickly.
This requires focus, effort, commitment, and collaboration, right across the supply chain from governments, product manufacturing/ production/distribution and must include wholesale, retail and commercial outlets and it must include the consumer and of course, the recycling industry itself, including organics recycling.
If we work together on tackling contamination, the beneficiaries of this are all of the above, and more broadly, our local communities and beyond.
Daily news updates at www.insidewaste.com.au APRIL/MAY 2023 INSIDEWASTE 37 // Organics
Can anaerobic digestion’s success in Europe be replicated in Australia?

Inside Waste talks to Dr Marc Stammbach, the Managing Director at global cleantech company Hitachi Zosen Inova’s (HZI’s) subsidiary in Australia. HZI is a company that specialises in renewable gas and waste to energy (WtE) and has its headquarters in Zurich, Switzerland.
In January this year, HZI announced its 20th Kompogas digester Italy that will treat 30,000 tonnes of organic waste. Tell us more about this project.
Italy has taken a step towards finding new solutions for dealing with municipal waste, particularly affecting the country’s south. This is where we shall build our new plant. Resource recovery and recycling have an important place in this fundamental reorientation of Italian waste management. Biogas technology, such as our Kompogas digester, is a step in this path towards
new solutions for dealing with organic municipal waste since it enables the recycling of biogenic municipal waste, leftovers from food production and green waste to generate renewable energy.
The project will start operation in late 2023 and produce sufficient power for approximately 2,200 households in the region.
It’s worth noting that HZI has more than 100 Kompogas reference plants globally, so our technology is well-proven, established and trusted.
A plug-flow digester in a reinforced concrete construction is at the heart of
the treatment process. Food and green organic (FOGO) waste is mixed and degassed under anaerobic conditions by a horizontal longitudinal agitator with plough-shaped paddle heads in the digester. The digester produces biogas, which is converted into electricity in a power plant. It can also be exported into the gas grid as renewable biomethane.
Why is HZI’s anaerobic digester successful in this region and Europe? Waste management regulations prioritising resource recovery and
recycling are critical to successfully rolling out sustainable waste solutions such as anaerobic digestion. In combination with the right incentives, as found in Europe, we see a nourishing place for the biogas industry to flourish.
One incentive is mandated source separation of municipal waste into organics, recyclables and residual waste. Source separation provides a viable, consistent organic waste stream suitable for anaerobic digestion. This year, for example, the UK regulators have gone a step further and mandated the separate collection of organic
Organics // HZI’s Dry AD Kompogas facility in California, which processes 33,000 tonnes per annum of FOGO.
Daily news updates at www.insidewaste.com.au 38 INSIDEWASTE APRIL/MAY 2023
kitchen waste. Hence, the waste industry can unlock 1.5 million tonnes of additional food waste suitable for energy conversion.
Another incentive is the European Commission’s commitment to increase biomethane’s annual production and use to 35 billion cubic metres by 2030. Hence, the Commission’s Biomethane Industrial Partnership (BIP) – a collaborative initiative between industry and regulators – was created. We are a member of the BIP. The current total European biomethane production is just over 10 per cent of this goal.
These are concrete examples of commitments in Europe. Another example is carbon credits at a level that provides sufficient incentive to prioritise anaerobic digestion over composting. For example, Europe trades carbon credits at approximately 85 Euros or just over $155 per tonne. Compare this to the Australian Carbon Credit Unit (ACCU), which sells at around $35 per tonne. The robust carbon incentive encourages biogas technologies with zero methane leakage, such as HZI’s continuous dry and wet anaerobic digesters.
Furthermore, the disruption in the global energy markets due to the current geopolitical situation in Europe also provides further impetus to maximise biogas production and reduce reliance on externally sourced fossil energy.
Biogas is also ‘dispatchable’ because it can be intermittently stored and used as required to meet peak energy needs. Clear and consistent incentives are available in Europe for building a viable business case for anaerobic digestion plants.

Why is anaerobic digestion not as prolific in Australia?
Australia has a fragmented, stateby-state and council-by-council set of waste management approaches and regulations. For example, statemandated source separation – a fundamental prerequisite for anaerobic digestion of organic waste – is still only in discussion or implemented as a toothless policy. Hence, many councils see it as a vision and keep their timelines open without clear and consistent consequences for not meeting them.
HZI and the Australian waste industry would welcome a federal approach that is aligned with the waste hierarchy principles, more significant carbon credit incentives, and the use of landfill levies for infrastructure development grants. Such steps will unlock the full potential of the anaerobic digestion market.
Today, proponents seek other avenues to create a viable case for anaerobic digestion without explicit regulatory drivers and incentives, such as applying a ‘green’ premium for biogas injected into the gas network. However, this will unlock only a tiny market share at best.
Furthermore, there is too much focus on safeguarding landfills. Landfill gas projects accounted for almost one-third of all ACCUs issued under the Government’s Emissions Reduction Fund. Instead, the Government disproportionally incentivises landfill gas capture.
Landfills emit fugitive methane with a more negative greenhouse gas
impact than carbon dioxide. Previous studies have indicated that landfills need a gas capture rate of 97 per cent to become carbon neutral. The upper range of landfill gas capture rates is 70 per cent, but typically more in the 40-50 per cent range. Hence, landfills are net emitters of greenhouse gas. However, the Government financially incentivises landfill gas capture and forgets about the associated collateral fugitive GHG emissions. Instead of receiving ACCUs, the science says landfills would have to buy 10 to 20 times the current ACCUs benefit. Hence, landfill costs would rise strongly and send a financial signal for source separation. The call would be even stronger if we applied the price of European carbon credits, as discussed previously.
Nonetheless, HZI has a few anaerobic digestion projects in development. We shall make further announcements later in the year.
What type of waste is suitable for anaerobic digestion?
HZI’s Kompogas dry anaerobic technology is suited for food and green organics, which typically have 20 per cent to 40 per cent dry matter. We process wetter organic streams, such as food organics from kitchens and catering, grease, fats, dairy and manures, with HZI’s Schmack wet anaerobic digestion technology.
Both these plant types are modular, scalable and quick to deploy – a prerequisite for meeting the aggressive targets set for European biomethane production.
What are the important considerations when choosing where to build these anaerobic digesters?
Ideally, we locate a plant near the waste source to minimise transport costs. However, we typically find suitable areas for organics processing outside the primary collection area to avoid residential areas with a high odour complaint potential. We prefer sites with a buffer zone of at least 100 to 200 metres and regulatory protection against future residential encroachment.
Size also matters; ideally, we process at least 50,000 tpa organics in a Kompogas facility. Wet anaerobic digestion becomes viable with at least 25,000 tpa organics. Hence, we achieve economies of scale and a competitive gate fee.
The odour emissions from anaerobic digestion are similar to enclosed composting plants. The only difference is that there is an anaerobic digestion step before the aerobisation of the solid digestate.
It also goes without saying that one cannot build these facilities without the local community’s acceptance and recognition of the environmental and social benefits.
In summary, we need a clear and consistent Government policy that mandates resource recovery, recycling, and meaningful financial incentives for renewable energy against the protectionism of landfills. Then, we shall land the same successes we see in Europe or North America.
Daily news updates at www.insidewaste.com.au APRIL/MAY 2023 INSIDEWASTE 39 // Organics
The West AD facility showing: 1) entire plant; 2) raw material handling; 3) waste charging; 4) digester; 5) combined heat and power unit; 6) fermentation residue storage.
Future proofing the organics sector
GEORGE Hatzimanolis has always had foresight. He spent the best of the 14 years in the roading sector before he found his calling in the resource recovery industry, which led him to found Repurpose It almost six years ago. Since the decision to start the company, it has been full steam ahead.

As the name suggests, the company is all about trying to recycle the various products that it collects – separating them into a variety of waste streams and then on-selling them to third-party vendors. However, nothing comes cheap in the waste/resource recovery sector, especially when it comes to infrastructure. And this is where Hatzimanolis’s foresight – or intuition, call it what you will –comes into play.

With a government mandate that the country reach an 80 per cent target of waste being diverted from landfill by 2030, Hatzimanolis knows that in order for that to happen capital investment is a must. When it comes to organics he took a future-focussed approach – he set out to build a plant that was capable of processing organics. It has been a calculated risk, but one he is confident will pay off over the next few years. However, it hasn’t been a seamless process.
“Unfortunately, not a lot of the infrastructure is manufactured in Australia,” Hatzimanolis said. “This means there are long lead times. Which means when we’re planning these infrastructure investments there are many
considerations including how long it takes to source the technology from overseas and then get it delivered. Then there is the overlay in terms of getting the regulatory approvals, which can also take a significant amount of investment and time. You really need to be planning well ahead of when this infrastructure is needed.”
He said that all those factors, combined with the industry “chasing its tail” to meet the 2030 targets, is what prompted Repurpose It to make its investment decisions. The result is that it is ahead of the pack in terms of doing its part in helping the country meet those targets. Interestingly, Repurpose It has instigated the build of some of its infrastructure without securing some of the feedstock. This is where Hatzimanolis makes a couple of important points.
“We’ve been willing to make largescale investments and bring on capacity
before we’ve had all of the volumes contracted, knowing that the day will come when we will be needed,” he said. “If businesses like ours don’t start making those leaps in terms of building this infrastructure, then the country is not going to reach these targets.”
As mentioned, these are calculated risks. Hatzimanolis and other directors of the company don’t make the decisions lightly. He said they are willing to invest in best practice technologies as long as there are strong market drivers supporting and underpinning the needs of the industry.
He believes that there is some disconnect between the contracting and tendering process and the ability for those contracts and tenders to be fulfilled – especially if there is a lack of infrastructure.
“What I think is there is still a bit of a lag is in what happens with the overflow
with the existing providers when they don’t have capacity,” he said. “If there’s existing contractual agreements in place, and those facilities are at capacity, how are we going to deal with the additional volume that’s going to come online? Also, how are we going to put the additional procurement processes out to provide new facilities that are building capacity?
“A lot of the contracts that are in place are very long term. We know there are capacity constraints, and the rollout of FOGO is only adding to those capacity constraints. However, there have not been overflow tenders released in the kerbside space.
Daily news updates at www.insidewaste.com.au 40 INSIDEWASTE APRIL/MAY 2023 Organics //
Repurpose It CEO George Hatzimanolis at his company’s Epping precinct.
So that’s been a bit slow.”
The other issue, he said, is around the commercial sector. What are the drivers and how will policies be rolled out across the other commercial sources of food waste? What will help divert organic waste from landfill?
“We forecast that with the increase of landfill levy that a business like ours – when they invest in this large infrastructure – can provide a commercial incentive to those customers,” he said. “But it’s really understanding how the government’s going to roll out their policy across that sort of commercial sector in a way that is more than just a commercial benefit. Because for us to hit these targets, it is important that we fast track the infrastructure and have some strong policy guidelines about sending organic waste to landfill.”
Repurpose It’s organics facility will have the capacity to process up to 215,000 tonnes of organic waste per annum, including liquid and food organics, as well as grease trap residue and FOGO. Part of the infrastructure includes 20 composting tunnels. It will also have an EPA-approved food de-packaging plant and an anaerobic digester that will produce biogas. Does Hatzimanolis worry that the plant will not reach its capacity?
“If we’re going to meet our policy objectives that we’ve set as a state, and at a national level, then we definitely will have our capacity filled because we’re
still only a small portion of what needs to be diverted from landfill,” he said. “In Victoria, it’s still north of 700,000 tonnes of organics that need diverting. We’re already doing between 50,000 and 100,000, so even an additional 150,000 tonnes are less than 30 per cent of what we need to divert.”

Currently, Repurpose It supplies up to 500 customers with bark, mulch, and soil compost from its facilities.

Hatzimanolis said he sees the company not as organic waste processors, but repurchasers of organic resources that can be reused. He said that this reselling of
repurposed materials is a growing part of the business, which is turning out to be a success.
“It’s about having the diversity in the channel – we sell a lot of soil,” he said. “We have an extensive customer base and that’s what gives us a point of difference from many other organic waste processors.”
Five to 10 years down the road, Hatzimanolis can see the company expanding as it reaches the limits of its current licenced approvals. Any new plant might not necessarily be at its Epping site – although there is still plenty of room at
the precinct – but could be in other areas of Melbourne, or even Victoria.
If he has a final word, there is one area that he thinks needs addressing in the organic waste space, sooner rather than later – source separation, collection and transportation.
“Unlike kerbside collection, where we can roll out a new system for FOGO and go to weekly bins, in the commercial sector, where there’s actually significant portions of commercial organic materials still going to landfill, that requires an industry solution,” he said. “That means there needs to be more source separation at places like manufacturing facilities, catering places and other venues. To be able to get source separation infrastructure in place, you’ll also need collection routes that warrant the effort to do single-source collection runs.
“That takes economies of scale that’s really going to need industry to step up otherwise we’re just not going to get this organic waste separated in a form that can divert them from landfill. And I’m concerned that we’re a bit behind where we need to be in that space. Ultimately, we still need some predominantly organic waste material collected as a single substance as opposed to being mixed with municipal waste because if it’s coming in a standard municipal waste bin there’s too much to be separated.”
Daily news updates at www.insidewaste.com.au APRIL/MAY 2023 INSIDEWASTE 41 // Organics
Repurpose It’s organics facility will have the capacity to process more than 200,000 tonnes of products.
There needs to be strong government guidelines around sending organics to landfill.
Australia first trial to solve growing aged care waste problem
HALF the landfill waste from Australia’s residential aged care facilities is used incontinence products, but when operators started looking for more environmentally sustainable disposal solutions, they found there were none – so Essity, who manufactures and supplies incontinence brand TENA, launched Australia’s first trial to find a better way.

Rochelle Lake leads Essity’s Project Divert, an industry collaboration that is assessing the suitability of pyrolysis technology to dispose of incontinence products during a six-week trial funded by the Commonwealth Government National Product Stewardship Investment Fund.
Lake said when customers started asking for a better solution than landfill, she and her team explored what the waste industry could offer. It turned out no one in the sector had a viable alternative.
“We’ve been in pursuit of a more sustainable option for several years. Aged care facilities are eager to contribute to a more sustainable future, and so are we. As a product manufacturer and company that is committed to sustainability and making advances with full life cycle management of our products, we chose to innovate in this space,” she said.
The Project Divert trial, launched in early February 2023, is based in regional Victoria at the Med-X Healthcare Solutions facility in Sale. The trial utilises patented pyrolysis technology
developed in Victoria by Earth Systems, which heats waste materials in the absence of oxygen, meaning lower emissions than traditional incineration. The waste is converted to a biochar that may have various commercial applications.

“We have an aging population in this country and incontinence product use is rising, so finding a way to deal with this waste is critical,” Lake said. Currently, incontinence products used in aged care account for 18,000 tonnes of CO2 emissions from landfill each year or the equivalent of 10,000 cars on the road, and this is rising due to our aging population. Estimates suggest the amount of absorbent hygiene product waste produced by adults could be up to 10 times that produced by infants by 2030.
The cost to aged care facilities is financial as well as environmental.
“Right now, an estimated $5.6 million is spent on landfill levies each year to dispose of used incontinence products, which is a huge cost burden for stretched aged care budgets, on top of the obvious environmental concerns,” Rochelle says.
The Project Divert trial involves 10 waste collection sites across Victoria, and will process approximately 16 tonnes of waste over six weeks.
Arcare Knox Aged Care in Wantirna South is one of the participants in
the trial. The 115-resident facility uses more than 1,200 incontinence products each week.
CEO Colin Singh said he’s hopeful that Project Divert will unlock new disposal options.
“...We are very keen to find a more environmentally responsible and cost-effective way to deal with incontinence product waste. Within our facilities we have implemented a range of sustainability initiatives, and hope that this solution assists us with our strategy of being more sustainable.
Lake said that when the six-week commercial trial concludes, TENA and Essity will assess the feasibility of a more permanent solution for our customers.
“Essity is dedicated to improving well-being through leading hygiene and health solutions, while reducing negative impacts on the environment and minimising our carbon footprint. This is just one of the many initiatives we’re working on to help our customers, and the industry become more sustainable and protect our planet for the future.”
Daily news updates at www.insidewaste.com.au 42 INSIDEWASTE APRIL/MAY 2023 Medical Waste //
Waste from incontinence products are turned into biochar for secondary uses.
Absorbent hygiene product waste produced by adults could be up to 10 times more than produced by infants within the next decade.
Spirit bottles should be in CDS
open across Queensland it’s timely to look at expanding the program to include a wider variety of recyclable food and beverage containers, including wine and spirits.

“The ABCL believes container deposit schemes such as Containers for Change are about more than just preventing littering and keeping containers out of landfill, but about obtaining and reusing quality materials to support a sustainable, circular economy.”
Queensland Environment Minister Meaghan Scanlon visited one of the state’s newest container refund points at Dundowran in Hervey Bay. The site employs six locals and more than 4.5 million containers have been returned through the depot since opening in late 2022.
Meaghan praised Hervey Bay locals for their support of Containers for Change, adding that enthusiasm
the possible expansion of the scheme to include wine and spirit bottles via a government survey that was in the public domain.
Natalie Roach, the new chief executive officer of Container Exchange, the not-for-profit that runs the CDS, said that 2023 is set to be an exciting year for the enterprise.
“Containers for Change has put more than $590 million back into the pockets of Queenslanders, with an additional $10 million going to charities and community groups,” Natalie says.
“We’ve got one of our biggest years ever ahead of us, as we open our first refund points in the Torres Strait and continue to expand the network to allow convenient access to the scheme to all Queenslanders.”
Currently Queensland, New South Wales, Northern Territory, South Australia, the Australian Capital Territory
CONTAINERS for Change celebrated the six billionth drink container returned through the network of more than 360 container refund points in Queensland, following a record-breaking summer for the scheme.

Containers for Change launched in November 2018 providing 10-cent refunds for eligible drink containers and hit the five billion container milestone in July 2022.
Many regions across the state broke their records for numbers of containers returned before Christmas, while Brisbane residents started the new year in green spirit, returning 17.4 million containers in the first week of January alone.
More than 150 million containers were refunded across the state in January 2023, with more than $15 million refunded to individuals, community groups and charities.


The Australian Beverages Council, Limited (ABCL), which has contributed to

the design of container deposit schemes (CDS) across Australia, celebrated the Queensland milestone.
Geoff Parker, Chief Executive Officer ABCL, says it’s pleasing to see strong uptake of container deposit schemes.
“A complex system like CDS has many moving parts,” Parker said. “The Queensland success is a testament to the efforts of COEX taking steps to expand the scheme with more facilities across the state.
“And, of course, to Queenslanders for making smart choices with their drinks packaging to support sustainability.
“We’re glad to see these successes – particularly the impressive amount of containers Queenslanders returned this summer, which helps schemes to keep containers out of landfill and put millions of dollars back into consumers’ pockets.”
Parker said as more collection sites
Daily news updates at www.insidewaste.com.au APRIL/MAY 2023 INSIDEWASTE 43 // Container Deposit Scheme
Queensland Environment Minister Meaghan Scanlon visits the state’s newest container refund point at Dundowran in Hervey Bay.
More than $490 million was returned to Queensland via the CDS.
DO YOU KNOW A DRIVER OF CHANGE?
WOMEN IN INDUSTRY NOMINATIONS ARE NOW OPEN. Now is your chance to nominate an industry leader who you believe is advocating for positive change and deserves to be recognised.
WOMENININDUSTRY.COM.AU








THURS 8 JUNE 2023
The Women in Industry Awards recognise outstanding women leaders from across Australia’s industrials sector.


PROUDLY PRESENTED BY
SPONSORED BY Australia MHD Supply Chain Solutions
Soft plastics collection resumes for Sydneysiders
recyclers to ensure that everything gets properly recycled.”
In the case of the soft plastics, that partner is the aforementioned APR Plastics. At the centre, the plastics are bundled together into bales. Once there is enough of them, they are collected by APR Plastics. When they arrive at the processing plant the plastics are shredded and fed into the P5000 machine. A corkscrew conveyor transports the plastic material into the reactor and breaks it down at high temperatures. The plastic is then converted into feedstock oil. The feedstock oil is then sent to VIVA Energy’s Geelong refinery for further processing. From here it is turned into resin, which enables it to be turned back into food-grade plastic packaging.
Georgio Baracchi founded RecycleSmart just over 10 years ago, he started on a journey that would lead his company to become the Uber for waste. After the recent events around soft plastics, he sees his company’s foray into this collection space as more important than ever.
RecycleSmart, with its distinctive pink pick-up bags, collects textiles, e-waste and a range of other items. It has resumed its soft plastics collection service recently, and like any initiative, it helps to have a collaborator. In this instance it is APR Plastics, a company that has recently bought a P5000 Biofabrik WASTX pyrolysis machine, capable of converting soft plastics back into oil. Once the plastics are collected, they will be transferred to the APR facility in Victoria.


And how are they collected? The company uses its own software to create routes for drivers and optimise the collection of all the accepted items.
“You put any items we collect in any shopping bag you have at home; that includes your soft plastics,” said Baracchi. “When you are ready, you book a Power Pickup online. Thanks to the support of our council partners, residents are entitled to free recurring collections, usually every 4-6 weeks. If
they need more, they can pay for extra bag pick-ups.”
As well as providing a service to the community, Baracchi and his team see the service as more than just a way for valuable resources like soft plastics to be kept in circulation, it provides opportunities for employment in local communities.
“We hire local drivers so the majority of what we charge goes back into the community as local jobs,” he said. “The day of the Power Pickup, the driver takes a picture, then weighs and collects the bags before emptying them into the car. By sorting through the bag, the driver also ensures we only collect clean streams of recyclables.”
All this information is passed on to the councils so they can use the data to get a better understanding of the recycling behaviour of their residents. So far, the company has 25 drivers under contract who have already collected more than 400,000 kilos of resources.
“We pay above market rate. We have young mums, pensioners, and students. It’s a job where people have a spare three or four hours a day to do the collections. They’re also helping make sure that the planet is in a better shape than it is today,” he said.
“When they have roughly 25 bags in the car, they drive to a recycling centre where they put the items into different bins. We have partnerships with
The RecycleSmart program has been going for more than three years. Although it currently covers off on domestic customers, there is a plan to extend to the commercial sector. It will be targeting SMEs and similar enterprises. Services on offer will include the collection of e-waste, batteries and many other items as well as plastics. The company is also looking to scale up into the Melbourne and Brisbane markets.

Daily news updates at www.insidewaste.com.au APRIL/MAY 2023 INSIDEWASTE 45 // Recycling
RecycleSmart drivers have picked up more than 400 tonnes of recyclables.
RecycleSmart employs more than 25 drivers who pick up the various waste streams.
Melbourne’s
leading construction and major infrastructure event

Inside Construction Expo will deliver

Targeted messaging in over 19 industry-leading publications that reach more than 80,000 decision makers across multiple sectors
Digital communications to 28,000+ engaged readers
Premium networking opportunity with industry leaders at the Foundation Awards gala dinner
insideconstructionexpo.com.au
Melbourne
20-21
2023
Convention and Exhibition Centre
Sept
EXHIBITION SPACE NOW ON SALE
Komatsu Forest
Company Overview:
Komatsu Forest is one of the world’s largest manufacturers of forest machines. We are represented on six world continents by a network of dealers and our own sales companies.
Komatsu Forest’s head office is in Umeå, Sweden, and we have two manufacturing units, in Sweden and the USA. Our own sales companies are located in Sweden, Norway, Finland, Germany, Austria, France, United Kingdom, Russia, USA, Australia and Brazil, and our network of dealers represent us on all other important forestry markets.
Our extensive service organisation takes care of the machines, ensuring that they perform their best throughout their service lives. We have workshops throughout the world, service vehicles for quick assistance, in-house machine and methodology instructors to help maximise productivity, and support functions for everything related to our machines and services.
Products and Services:
We offer products and services that
increase productivity while simplifying the working day for you as a machine owner.
We combine all our services under our Customer Care concept. This is our promise that you will enjoy the benefits of Komatsu Forest’s investments in research, development, servicing, support, logistics and innovative services. These combined resources are at the very heart of Komatsu Forest’s offer.
Our goal is to make your working day as safe, problem-free and profitable as possible, no matter where in the world you operate. Let us show you that by choosing Komatsu, peace of mind and accessibility can become a natural part of your working day.
Brands
• Komatsu
• Peterson
• TimberPro
Core Capabilities:
Our world-wide network of highly trained service professionals is ready for you. We know how important it is to be
Hitachi Zosen Inova
Company Overview:
Hitachi Zosen Inova (HZI) is a global leader in energy from waste (EfW), anaerobic digestion (AD) and Power-to-Gas, acting as an engineering, procurement and construction (EPC) contractor delivering complete turnkey plants and system solutions for energy recovery from waste. Since 2015, HZI Australia, a 100% subsidiary of HZI, is developing new projects in Australia, New Zealand, and the South Pacific. Its first project, the 300,000 tpy East Rockingham WtE is now in construction and will start commercial operation in 2023.
Products/Services:
• Thermal treatment of residual waste, energy recovery, flue gas treatment, and residue recycling

• Wet and dry anaerobic digestion of food & green resources, renewable power production, biogas upgrading to biomethane and bio-CNG
• Power-to-Gas for volatile electricity into renewable synthetic gas for a carbonneutral economy
• Development, Design, Build, Finance, Own, Operation & Maintenance
Brands:
• Hitachi Zosen
• Aquaroll, DYNOR, Kompogas,
• HZI Etogas, HZI DryMining
Core Capabilities:
Energy from Waste, Renewable Gas, Project Development, EPC, O&M, Asset Management
Recent Projects/Installations:
RIVERSIDE 2 ENERGY FROM WASTE FACILITY, LONDON, UK
Leading waste and recycling company Cory Group (Cory) has further strengthened its relationship with Hitachi Zosen Inova (HZI) by awarding the Swiss green-tech company with the Engineering, Procurement and Construction (EPC) contract to build its second large-scale energy from waste (EfW) plant at Belvedere in the London Borough of Bexley. The site is adjacent to Cory’s existing Riverside 1 facility, which was also built by HZI and has been operational
close to service and maintenance when help is needed. Therefore, we have a market-wide network of highly trained service professionals that knows your Komatsu, Peterson & Timberpro machine in every detail. They are, in turn, in constant contact with the Komatsu Forest head office so your voice or needs are never more than a call away from our collective expertise. Furthermore, we are constantly developing new services that will help you in your everyday work.
We offer:
• Workshops and field services throughout Australia & New Zealand
• Well qualified personnel with expert knowledge of Komatsu & affiliated machines

• Field Service that enables us to remain close to you and your
machine
• Support and maintenance throughout your machine’s service life
• Maintenance agreements with fixed maintenance prices and other benefits

Contact Details:
AUSTRALIA
Komatsu Forest Pty Ltd
4/11 Ave of Americas
Newington, NSW 2127
T : +61 2 9647 3600
E : info.au@komatsuforest.com
NEW ZEALAND
Komatsu Forest Pty Ltd
15C Hyland Cres
Rotorua, New Zealand
M: John Kosar + 64 274 865 844
M: Paul Roche + 64 21 350 747
since 2011. For HZI, this new project represents its eighteenth EfW project in the UK to date.
The plant will utilise HZI’s well-established moving grate technology, which has successfully been deployed across numerous operational EfW facilities in the UK, including the iconic Riverside 1 facility. The plant will be able to treat 650,000 tonnes of non-recyclable waste while generating around 61 MWe of electricity (net) – enough domestically produced energy to power over 140,000 UK households each year.

Construction will start in January 2023 and once operational in 2026, the two-line plant will generate electricity through a steam turbine which will meet strict emission directive requirements and satisfy the high demands placed on modern EfW facilities.
Together with the existing Riverside 1 facility, the Cory sites will treat 1.3 million tonnes of residual waste per year within
a major metropolitan area. Treating waste close to its source reduces the need to transport large volumes of waste over long distances and the associated negative carbon impact this will have on the environment.
For more information visit: https://bit. ly/3XqcbqT
Contact Details:
Hitachi Zosen Inova Australia Pty Ltd Level 16, 1 Denison, North Sydney, NSW 2060

Phone: 02-8003 4110
Email: info@hz-inova.com
Web site: www.inova.com
Key Contacts:
Dr Marc Stammbach
02 – 8003 4110
info@hz-inova.com
Daily news updates at www.insidewaste.com.au
APRIL/MAY 2023 INSIDEWASTE 47 // Capabilities Statements
Ecostar Dynamic Disc Screening
Company Overview:
Ecostar is synonymous with state of the art technologies in the mechanical separation of waste and the waste materials sector. Thanks to Dynamic Disc Screening technology, many types of waste can be used efficiently today as clean fuels and energy sources.
Ecostar has been manufacturing their fast and versatile screening technology for over 25 years, and has been active in Australia and New Zealand with partner CSS Recycling Equipment for more than 10 years.


Ecostar’s market is primarily manufacturers of waste disposal plants and those for the production of biomass, ecofriendly fuels and compost, renewable energy, and both public and private utility and multi-utility companies.
Ecostar has developed specific screening products and technologies to separate different materials, even the most difficult ones, while ensuring the highest quality of separation, high volumes and low maintenance costs.
Brands:
• Custom collaborative screen design & complete plants
• Mobile Ecostar Hextra
• Static Ecostar Hexact
• Static Ecostar Easyone
Core Capabilities:
Dynamic Disc Screening (DDS) DDS is a series of shafts equipped with hexagonal or octagonal discs, with a flat profile, made of Hardox to guarantee maximum resistance. The material flows on the screen’s discs and is subjected to a jolting movement that separates waste. Undersized material drops below the screening surface, passing through the gaps between the discs while the oversized material advances to the end of the screening plane. The result is a clean fraction,ready for recycling processing.
Hyper Dynamic Disc Screening (HDDS) HDDS is for the separation of particularly difficult waste containing
Australasian Specialty Coatings
Products and Services:
Flooring (Epoxy and polyurethane)
long and stringy materials, such as bags and plastic straps used for packaging, which can wrap around the shafts, or plastic bottles that can get stuck during the screening process.
Screening Width Adjustment Technology (SWAT)
SWAT is the patented Ecostar technology particularly efficient with materials such as PET and plastic, paper and cardboard and multi-material. SWAT can be installed on DDS screens in order
to quickly change the screening section on-site according to the customer’s production needs and the material to be screened.
Contact Details:
CSS Recycling Equipment Solutions
PO Box 359 Dee Why NSW 2099
Phone: 1800 644 978
Email: info@cssequipment.com.au
Web: www.cssequipment.com.au
Eriez Magnetics
Core Capabilities:
Company Overview:
Australasian Specialty Coatings – ASC – is an experienced coatings company located in Blacktown. We work in Construction and Maintenance and provide a range of Protective Coatings and Treatments for Concrete & Steel.

We have been established since 2003 and we have a strong track record in achieving outstanding results for our customers. ASC successfully works with a wide variety of customers including Sydney Water, Ericsson, Veolia Environmental and Water Services, Suez Water and Waste Services, Unilever, Coca Cola Australia, General Mills, Bega Foodservice, George Weston Foods, Diageo, etc.
ASC is an experienced organisation with ISO 9001, 14001 and 45001
Certified Management Systems as well as the NSW Government 5th Edition. We are also members of the Master Builders Association.
– Commercial & Industrial Floor Resurfacing, Concrete Remediation, Concrete Repair, Anti-Slip Flooring, Anti-Static Flooring, AGV Flooring, Self-Levellers, Demarcation & Line marking
Coatings for Concrete
Densifiers, Waterproofing Membranes, Sealers, Concrete Resurfacing, Epoxy and Polyurethane Flooring, Chemical Bund Linings, Acid-Resistant Coatings
Protective Painting Services
Abrasive Blasting, Vapour Blasting, Shot-Blasting, Corrosion Control Coatings, Chemical Resistant Coatings
Contact Details:
ASC Head Office
1/14 Chicago Avenue
Blacktown, NSW 2148
Phone: 02 8840 8888
Email: enquiries@acoatings.com.au
Web: ascoatings.com.au
Company Overview:
Leading specialists in metal separation, resource recovery technologies, and developing new recycling strategies and processes.
Products and Services:
• Magnetic Pulleys & Scrap Drums
• Ballistic Metal Separators
• Suspended Electromagnets
• Eddy Current Separators
• Stainless Steel Separators
• Fines Metal Recovery Systems
• Airless Metal Recovery Systems
• Tech Service and Repairs
Brands:
• P-Rex® Scrap Drum
• Shred1™ Ballistic Separator
• FinesSort® Metal Recovery System
• RevX-E Eddy Current Separator
Eriez designs and manufactures equipment to successfully recover and beneficiate ferrous and nonferrous metals. Identify and remove unwanted metal contaminates to minimise product rejection and maximise product purity. We can help you achieve greater recovery at a higher-grade product delivered at a lower cost per ton. Recover valuable resources from:
• MRF, MSW, C & I and C & D
• E-waste
• Tyre recycling and Scrap metal yards,
• Energy from waste feed and bottom & fly ash
• Green waste processing, composting and road sweepings
Contact Details:
Eriez-Australia
21 Shirley Way, Epping, Victoria 3076
Phone: 61-3-8401-7400
Email: sales.au@eriez.com
Web: www.eriez.com.au
Daily news updates at www.insidewaste.com.au 48 INSIDEWASTE APRIL/MAY 2023 Capabilities Statements //
Cooee - Waste Facility Data Solutions
Cooee
WASTE FACILITY DATA SOLUTIONS
Contact Details:
East Coast Office 0447 393363
West Coast Office 0422 525 985 solutions@cooeedata.com cooeedata.com
Company Overview:
Cooee provides a cost-effective gatehouse data solution for small to medium-sized landfills and transfer stations. We have a great team with decades of waste experience and dedicated data engineers who ensure that Cooee is set up to meet each of our customer’s unique needs and circumstances. Therefore, saving our customers from frustration and wasted time and money.
Products and Services
• Cooee – Waste Facility Data Solutions, inc:
• Conversion of volumes to tonnage by waste type
• Manage and monitor tip pass use
• Account holder management & invoicing
• Compliance data capture and reporting
• Operational oversight.
Core Capabilities:
We work with our customers to ensure that Cooee is customised to meet their needs and services. Easy to use, the accurate data from Cooee drives good decisions. You can check waste quantities and revenues at a glance, seamlessly manage tip passes and even work in off-line environments.
Recent Projects/Installations:
Richardson Road landfill and transfer station. Shire of Harvey. Customisation, installation, training and commissioning of Cooee at the Council’s waste facility. At the Council’s request, their version of Cooee includes operational and compliance facility checklists. These are sent to their Waste Officer to review and promptly act upon if there are any issues.
Landfill data systems. Shire of Derby West Kimberley. Due to the remote location of the facilities, Cooee’s ability to operate in an off-line environment is important. Cooee provides up-to-date account holder transactions for prompt invoicing.
Applied Machinery
Brands:
• Genox
• Meyer
Contact Details:
55-61 Nissan Drive
Dandenong VIC 3175
Phone: 03 9706 8066
Email: sales@appliedmachinery.com.au Web: www.appliedmachinery.com.au
Company Overview:
Applied Machinery is one of Australia’s largest suppliers of quality recycling machinery. Over 30 years industry experience enables us to deliver turnkey solutions for all manner of recycling applications across Australia.
Products and Services:
• Shredders and granulators
• Plastic washing, tyre, and e-waste recycling plants
• Repelletising systems/screen changers
• Optical Sorting Systems
MRA Consulting Group

detailed and practical advice to support your waste and resource recovery needs.
Core Capabilities:
Contact Details:
MRA Head Office Suite 408 Henry Lawson Building, 19 Roseby Street Drummoyne NSW 2047 02 8541 6169 info@mraconsulting.com.au www.mraconsulting.com.au
Company Overview:
MRA is one of Australia’s leading environmental consultancy firms, specialising in all aspects of waste and recycling. We are experts in waste, resource recovery and the circular economy, technology, climate change, carbon and sustainable development. Our vision of the future is one that is both environmentally sustainable and economically rational. With over 35 professionals in environmental science, engineering, law and finance, working across Australia we have the experience and technical knowledge to provide
Customised advice to all levels of government and corporations. Our objective is to collaborate with you from the initial briefing process through to project development and implementation of solutions specifically tailored to your needs in the fields of:
Strategy & Commercial – Innovative and tailored strategies
Circular Economy – Help move your organisation or material towards a circular economy model
Planning & Approvals – Development and planning approvals and licensing services
Contracts & Tenders – Preparation, review and assessment
Organics – Business case, collection processing and market development solutions
Grants – Scoping, application, writing, review and administration
Waste Education – Effective and engaging programs
Auditing – Research and compliance audits
Carbon – Climate adaptation, ERF reporting and accounting
Core Capabilities:
Applied Machinery has the capability to service the smallest single machine requirement, through to the largest of multi-site, staged installations and complete recycling line, turn-key projects. We supply some of Australia’s largest recycling organisations. A wide range of shredders and granulators are always in stock for quick delivery.
Recent Projects/Installations:
D&M WASTE MANAGEMENT
Perth
Genox J-Series Pipe Shredder feeding a plastics washing and pelletising system.
The J-Series pipe shredder features a multi-rotor design with long life counter knives ideal for shredding different diameter and sized pipes.
If you want access to all the major stakeholders in the waste industry then a Capability Statement is a great introduction to those decisionmakers, allowing your business to get a crucial foothold in a competitive market.
// Capabilities Statements
Daily news updates at www.insidewaste.com.au Capability statements are a popular medium in Inside Waste that give the industry an insight into your business –how it can help potential
the services you offer, and products you sell.
clients,
GET YOUR CAPABILITY STATEMENT IN NOW! If you want to know more about Capability Statements and how they can help your business Contact Chelsea Daniel-Young: Email: Chelsea.daniel@primecreative.com.au | Ph: 0425 699 878 APRIL/MAY 2023 INSIDEWASTE 49
Easy One
Unit Dimensions: from 3,000mm up to 6,000mm
Weight: Up to 8,000kg
Drive Type: Electric
Motor: Electric (Nord)
Rotor diameter/lengths/speed: 1,400mm Wide x (up to 6,000mm)
Speed (slow/high): Variable Speed Screening
Suitable material: Wood, Mulch/Compost, Green Waste & Tyres etc
No. of units in range: 4 x Models
Throughput: Up to 50tph of mulch materials.
Finished product size: Down to -15mm
Options/Extras: Static Models.
Price: Please Contact CSS Equipment for Pricing
More: Resistant, reliable and versatile stationary screen, the ideal solution for compost, tires, shredded C&D and wood. Easy One is available with 2 or 3 screening fractions and screening surfaces up to 6 meters in length.
Name: CSS Recycling Equipment
Phone Number: 1800344978
Webpage: www.cssequipment.com.au
Email: info@cssequipment.com.au
Hextra
Unit Dimensions: Multiple Models
Weight: Up to 22 tonnes
Drive Type: Electric or Diesel
Motor: Kohler Diesel
Rotor diameter/lengths/speed: Screen Lengths from 5,000mm to 7,000mm
Speed (slow/high): Variable Speed Screening
Suitable material: Most Waste Materials
No. of units in range: 2 or 3 Fraction Screening
Throughput: Up to 200tph (dependant on materials to be screened)
Finished product size: down to -10mm
Options/Extras: Magnet Pulleys on Discharge Conveyors and Air Vac Systems
Price: Contact CSS Equipment for more details.
More: Fast and Flexible, customised for your waste stream. Units in stock ready for immediate dispatch.
Name: CSS Recycling Equipment
Phone Number: 1800344978
Webpage: www.cssequipment.com.au
Email: info@cssequipment.com.au
Weight: Up to 23 tonnes
Drive Type: Diesel 375Hp
Motor: CAT C9
Rotor diameter/lengths/speed: 750mm x 2,000mm Slow Speed (High Torque)
Speed (slow/high): Slow Speed Variable between 18rpm to 36rpm
Suitable material: Most Waste Types
No. of units in range: 3 x Models (Electric, Semi-Mobile & Fully Mobile)
Throughput: Up to 50tph depending on Waste Materials
Finished product size: Down to 100mm
Options/Extras: Contact CSS Equipment for all Options Available
Price: Contact CSS Equipment for more information
Name: CSS Recycling Equipment
Phone Number: 1800344978
Webpage: www.cssequipment.com.au
Email: info@cssequipment.com.au
Weight: Up to 47 Tonnes
Drive Type: Diesel 760Hp
Motor: CAT C18
Rotor diameter/lengths/speed: 950mm x 2,750mm Slow Speed (High Torque)
Speed (slow/high): Variable between 18rpm to 36rpm
Suitable material: Most Waste Materials
No. of units in range: 2 x Models (Electric or Diesel)
Throughput: Up to 200tph (depending on material)
Finished product size: Down to 100mm
Options/Extras: Contact CSS Equipment for all Options Available
Price: Contact CSS Equipment for more information
More: *Overbelt Magnet *5000mm Discharge Conveyor *Gold Standard for hard to process waste *High Throughput *Minimal dust * Now quieter *User Friendly Handling

Name: CSS Recycling Equipment


Phone Number: 1800344978
Webpage: www.cssequipment.com.au
Email: info@cssequipment.com.au
 HAMMEL RECYCLINGTECHNIK
HAMMEL RECYCLINGTECHNIK
ECOSTAR DYNAMIC SCREENS ECOSTAR DYNAMIC SCREENS
VB750DK Primary Shredder
The Red Giant VB950DK Primary Shredder
HAMMEL RECYCLINGTECHNIK
HAMMEL RECYCLINGTECHNIK
ECOSTAR DYNAMIC SCREENS ECOSTAR DYNAMIC SCREENS
VB750DK Primary Shredder
The Red Giant VB950DK Primary Shredder
Product Profiles // Daily news updates at www.insidewaste.com.au 50 INSIDEWASTE APRIL/MAY 2023
ECOHOG RECYCLING EQUIPMENT SOLUTIONS
HSB-81 Air Hog
Weight: 500kg or 1,220kg
Drive Type: Electric or Diesel
Motor: Perkins Diesel
Suitable material: Most Waste Types
No. of units in range: 2 x Model
Price: Contact CSS Equipment for more information
More: Airhogs Vac Systems are used for removing light materials from heavy materials on conveyor belts. Fit most conveyor systems.
Name: CSS Recycling Equipment
Phone Number: 1800344978
Webpage: www.cssequipment.com.au
EQS 1200 SMQ Mobile Picking Station
Product/model name: EQS 1200 SMQ Mobile Picking Station
Weight: Up to 17 tonnes
Drive Type: Electric or Diesel
Motor: Perkins Diesel
Suitable material: Most Waste Materials
No. of units in range: 2 x Models (4 x Person & 6 x Person)
Throughput: Dependant on Infeed Materials

Options/Extras: Over-Belt Magnet and Air-Knife System
Price: Contact CSS Equipment for more information
More: The EQS is a semi-mobile Picking Station that can be operated in a static mode or moved from site to site.
Name: CSS Recycling Equipment
Phone Number: 1800344978
Webpage: www.cssequipment.com.au
Email: info@cssequipment.com.au
ECOHOG RECYCLING EQUIPMENT SOLUTIONS


EH1500 TWS Windshifter
Weight: Up to 17 tonnes
Drive Type: Electric or Diesel
Motor: Perkins Diesel
Suitable material: Most Waste Materials
No. of units in range: 3 x Models (Electric, Semi-Mobile and Mobile)
Price: Contact CSS Equipment for more information

More: Windshifters for operating on screened materials, to separate light materials from heavy materials.
Name: CSS Recycling Equipment
Phone Number: 1800344978
Webpage: www.cssequipment.com.au
Email: info@cssequipment.com.au
RECYCLING EQUIPMENT
ECOHOG
SOLUTIONS
// Product Profiles Daily news updates at www.insidewaste.com.au APRIL/MAY 2023 INSIDEWASTE 51 If you wish to let our readers know your latest machinery and its capabilities, then you should be in Inside Waste’s Product Profile section. GET YOUR PRODUCT PROFILE IN NOW! For more information on how to make the most of this opportunity contact Chelsea Daniel-Young: Email: Chelsea.daniel@primecreative.com.au Ph: 0425 699 878
Trucks that walk the walk
DISPOSAL and repurposing of tyres is a specialised form of waste manage work. S&J Australian Scrap Tyre Disposals is a company that specialises in disposing of scrap tyres. To do so efficiently, the S&J Australian Scrap Tyre Disposals team needed the right equipment to meet the company’s requirements.

One of the key elements to its business is its fleet of Isuzu trucks. They are an integral part of making sure the operation runs smoothly. The business has a variety of vehicles ranging in size, the smallest being an Isuzu ute, with the biggest being the Isuzu FXL 240-350, which is the heavy, rigid model.
Operations manager of S&J Australian Scrap Tyre Disposals, Josh Hayes, has been thoroughly impressed with his Isuzu FXL 240-350 walking floor trucks.
As the name suggests, these trucks take a lot of the manual labour out of picking up tyres.
“Our day-to-day operation is that we pick up scrap tyres from councils, tyre stores and from anyone that generates waste tyres,” Hayes said.
“They’re brought back to a depot
for recycling. Where walking floor trucks come into it, is that they can reduce the manual handling side. Some of the high-volume tyre stores have the tyres rolled up and ready to go when our guys arrive. They can load the truck in 15 minutes thanks to the walking floor trucks.
“Then when you get to the depot you just press a button and they more or less unload themselves.”
The trucks have a capacity of about 800 passenger units, which is about 400 four-wheel drive tyres or a couple of hundred truck tyres depending on their size.
This is paramount to the operation of the business as it provides efficiency for the team’s workday.
The company bought its first Isuzu truck back in 2008, and it is still in service. Initially, S&J Australian Scrap Tyre Disposals used cage trucks with an open top to pick up the tyres, whereby they could roll a tarpaulin over the top to prevent tyres coming loose.
Loading and unloading of scrap tyres is labour intensive. With the health and safety of its workforce in mind, the business has been innovating and implementing reductions in
manual handling in a continuous process to better care for its workers. Investing in their Isuzu Fleet has saved the company on down time as well.
“With the local runs, we’re saving at least an hour of work,” Hayes said. “At the end of the day, when the guys have just driven back from loading the truck, they want to be able to wrap the day up quickly with the press of a button, get the paperwork out of the way, and then go home.
“The other good thing about these trucks is that when they arrive back at 9-10 o’clock in the morning after their first run we can reduce that bottleneck if the unloading happens quickly and efficiently.”
The expansion of the Isuzu Fleet has reduced overtime markedly, which has led to higher productivity, and being able to carry heavier loads with an increase in efficiency, and of course less strain on the workers.
Hayes chose to go with the automatic transmission for the fleet in a smart move to increase the pool of candidates for the company’s workforce.
“Almost all the trucks are now automatic, which is handy because our
job applicants have licences driving automatics, but less applicants have a manual licence, which means the prospective pool of job hopefuls has increased,” he said.
But by far the biggest part of the Isuzu equation is the back-up service.
Realising time is money for its clients, Isuzu Trucks’ service workshop operates at night, which means S&J Australian Scrap Tyre Disposals can drop a truck off for an overnight service and pick it up in the morning, with less down time for the company.
“To be able to drop off our FXL 240-350’s on a Thursday or Friday night means we can plan a schedule for regular work on the following day,” said Hayes.
“Because if we miss a load due to a truck being serviced, it’s very difficult to catch up unless you’ve got the additional capacity in the fleet.”
The company has been happy with its relationship with Isuzu Trucks and plans on using them in the future to meet its fleet needs.
“We started buying Isuzu Trucks because of the price but we have continued to do so because of the reliability,” Hayes said.
Daily news updates at www.insidewaste.com.au 52 INSIDEWASTE APRIL/MAY 2023 Equipment News //
Huge time savings is just one of the reasons S&J Australian Scrap Tyre Disposals uses Isuzu trucks.
Reliable Komptech Advanced Fine Metals Recovery
FOGO (food and garden organics), in-vessel composting, and anaerobic digestion are the buzzwords of the organics recycling world.
Komptech CEA’s National Product Manager, Deon Cope, said there is no shortage in demand from organics businesses processing green waste in outdoor windrow operations.
Cope said Komptech’s Crambo shredder and Topturn compost turners are designed for businesses that need to optimise their composting process.

“The Crambo is Komptech’s main shredder for organics applications,” Cope said. “It features a large cassette that sits below the rotating shafts, and can be fitted with various screens, which are easily interchanged to size shredded material according to the desired end-product.”
Cope said the Crambo’s dualshaft, high-torque, low-speed design makes it unique in the market.
“The benefits of this shredder include reduced operating costs and wear and tear or damage from feedstock contamination like steel or concrete.”

CEA offers the Komptech Topturn
in four models: the X4500, X5000, X63, and the X6000, which cater to progressively larger sizes of windrow.
“The larger the size means the wider and higher the row height,” he said. “There is an optimal windrow size when it comes to aeration, moisture content, and management of the rows. The right choice for a customer will ultimately come down to the type and scale of their operation, as well as their budget.
“There are additional options, from standard cameras to 360-degree cameras to irrigation devices. Irrigation is popular in Australia due to the climate, so we always tend to option them as ‘irrigation ready’, which is also valuable from a resale value point of view. Both machines run Cat diesel engines, so you’ve got that commonality of parts between the two,” Cope said. “The same goes for our hydraulic and electric components. Shredders and turners are essential machines for composters, so uptime is critical. Fleet operators can manage multiple machines through one common telematics platform, Komptech Connect.
“This provides operators with fuel management, service management, and types of usage data, including the ability to monitor machines for any service intervals and fault codes.”
Cope said this can help CEA prepare for a customer’s service needs in advance.
“We’re trying to get to a point where we can notify the user when one of their machines is 100 hours or so away from their next service, so they can start planning,” he said.
Eriez eddy current separators utilise high-strength rare earth permanent magnets to extract course to ultra-fine nonferrous material from product streams. Working on the principle of induction, eddy current separators use a permanent magnet circuit operating at high rpm to separate any magnetic material. By inducting eddy currents and their repelling forces, the alternating magnetic field selectively repels the nonferrous metals and physically separates them from other materials with minimum to no product loss. The separated metal is then collected for further processing or recycling while the remaining product continues on its way through the process, unaffected by the magnetic field. The separators feature permanent magnetic circuits that employ rare earth magnetic material for stronger eddy currents and improved separation of nonferrous materials. Options include RevX-E eccentric eddy current separators and ultra high-frequency eddy current separators.
The RevX-E features large panels
for easier servicing. The rack-andpinion splitter adjustment allows for simple and precise splitter placement for optimum separation. Users can choose from four sizes and two different rotor assemblies, enabling customisation based on specific needs. One feature is the integration of a cantilevered frame, which enables maintenance personnel to change the belt in under 10 minutes.
The ultra high-frequency eddy current separator uses a high gauss rotor combined with magnetic poles operating at higher RPMs to remove fine nonferrous material. This model is paired with a Eriez brute force feeder for optimal separation results. Separating challenging materials such as bare copper wire, aluminum, and other nonferrous material as small as 2mm is quick work for the heavy-duty ultra high-frequency unit. This model comes with precise rack-and-pinion splitter adjustment. This line has proven particularly effective when used to separate automobile shredder residue (ASR), PET plastic fines and bottom ash processing.

Taper-Slot Screen Meets Needs
The Taper-Slot screen is designed to excel in applications that conventional screens can’t handle.
Unlike standard finger screens, the Taper-Slot has patented lateral wedge members, which prevent material from shifting laterally and catching under or wrapping around fingertips.
Wedge deflectors prevent longer, often oversized materials from free-falling into the screened fraction. Instead, they contact the screen’s formed ‘tail’ portion and are conveyed downstream for discharge with the oversize.It combines long-stroke vibratory action with a screen design that provides smooth, continuous material flow and efficient
separations. A material cascade at the mid-point of the Taper-Slot helps turn over material and increase downstream screening efficiency.
Multiple sizes can be screened per unit, and modular screen sections are easily changeable. Distributed in Australia by Lincom, the TaperSlot has a proven track record in screening a variety of applications, including construction and demolition, scrap tyres, wood waste, compost, aggregate and dirt, commercial waste, glass, plastics and metal and refuse derived fuel.
Each Taper-Slot screen is customised to meet specific application requirements.
// Equipment News
Daily news updates at www.insidewaste.com.au APRIL/MAY 2023 INSIDEWASTE 53
Multiple sizes can be screened per unit.
Eddy current separators work on the principle of induction.
The Topturn compost turner can help optimise a business’s composting process.
The Big Change..... Switch with Simplex Waste
Did you know?
Everyday, multiple waste collecting vehicles from different providers pass through your suburb, sometimes right past your business’ front door.
Simplex Waste is able to manage your waste efficiently by utilising its network of trucks that it manages, which are already on the road to collect your waste. This elite operating model offers financial and environmental advantages to a business by decreasing emissions, road congestion and striving for sustainable outcomes.
Unlike traditional waste companies, who negotiate rates at the landfill, Simplex negotiates on your behalf with the service providers. Due to its extensive network across Australia, it is able to leverage off its suppliers and provide its clients with the most competitive rates as well as making transport costs virtually zero.

Who Are Simplex Waste Solutions?

Simplex Waste Solutions is an Australian-owned and operated company that specialises in managing and providing tailor-made solutions within the waste and recycling industry. Its consultants are experts in being able to identify what is required specifically for your particular waste generation. It takes all the waste management time off your hands.
What does it offer?

Simplex Waste’s one stop shop
offering and capabilities are limitless for a variety of reasons. Simplex has ongoing relationships with expert service providers across the nation that it is able to leverage off due to its extensive customer base and large waste volumes.

First, it is flexible. Simplex will find a service provider to fit a company’s specific needs. It manages multiple trucks that are already on the road which individually collect different recycling materials eg: plastics, cardboard,glass, timber, food
organics, liquids as well as solve your problematic waste. Not only that, it’s not afraid to make the hard calls if the current service provider is not meeting a client’s requirements and will help the client navigate towards an agreeable outcome. Second, it is committed to making sure your project sustainability targets that have been agreed upon, are met. Finally, transparency. When it comes to annual fees and charges from service providers, Simplex will make sure they are fair and will provide one itemised invoice, reducing your administration costs.
Sustainability
The company is passionate about promoting sustainability to preserve Australia’s environment and is committed to making sure this happens in the most cost-effective way. At the core of Simplex’s business model is sustainability. It offers a Strategic Sustainability Plan that will be custom designed to the client’s needs. These solutions are outlined in a clear, concise manner and highlight the responsibilities of costs for implementation. The targeted plan will make sure that
high-quality recyclables make their way to a processing facility where they can be made ready for reuse.
Outcomes
Simplex Waste Solutions’ Sustainability Plans are managed and implemented via a year-on-year process. The company’s consultants can identify best waste practices, what waste streams need implementing when, and have processes in place to outsource for any problematic waste and recycling streams. This ensures that products go directly to the end user for reuse for best results.
Reporting
Simplex Waste Solutions has an extensive reporting system that allows clients access to data analytics. These reports are given monthly. The reporting system allows users to use filters to take a deep dive into the amount of volumes being created, where the waste streams are being diverted, and what amounts are being recovered.
Simplex Waste Solutions
1300 052 334 enquiries@simplexwastesolutions.com www.simplexwastesolutions.com

Company Profile //
Daily news updates at www.insidewaste.com.au 54 INSIDEWASTE APRIL/MAY 2023
Lauren Abbott - National Senior Waste Consultant Shelley Barbuto - Partner


UNLOCK A WORLD OF INSIGHT AND OPPORTUNITY BY SUBSCRIBING TO INSIDE WASTE PREMIUM Corporate subscription $445 5 members Inside Waste News & Networking twitter.com/InsideWaste or visit www.insidewaste.com.au/subscribe SUBSCRIBE NOW at subscriptions@primecreative.com.au Individual subscription $295


Connecting talent with industry. powered by careerone hiring.insidewaste.com.au ADVERTISE JOBS TODAY
Frustration leads to career in resource recovery
COVID has affected people in different ways. Whether it be having to work from home, short supplies of household goods, or having to temporarily find other employment, the impact has been felt in all facets of life.
In the case of Christian Pagliaro, it led to a change in career. At the beginning of the pandemic, the current Local Government New South Wales (LGNSW) senior policy officer – waste, was leading a sales team selling the

a typical week/day like for Pagliaro?
“Writing a lot of submissions to state governments,” he said. “They often want our input as a sector. It may be about a new policy they’re developing or looking at changing en existing practise. We’ll prepare a submission and go to our member
“We also do a lot of information exchange; to be the conduit between state government and councils. If a local council has an issue, we’ll take that to the state EPA who we meet with once a month and vice versa. If the EPA wants to get a message out to local councils, they can do that through us.
It’s diverse and interesting and there is
A lot of the issues he deals with other sectors of the industry – not enough levy money getting back to the industry, kerbside contamination, educating the public, and the need to redesign packaging so it is easier to recycle. However, one of his biggest concerns is one that has come to the fore a lot over the past two years.
“The lack of infrastructure is a big
one,” he said. “A lot of councils are concerned about the lack of FOGO infrastructure with the 2030 mandate coming up. You’ve got a bunch of big money that wasn’t around in the waste sector – from what I understand –10-15 years ago, now circulating in the space. It’s ready to be deployed quickly if there’s certainty in the contract. We just had 14 councils in New South Wales, the equivalent of 290,000 households, given the green light to go FOGO with the latest FOGO grants. That’s a whole lot of material that will be going out to tender soon. And off the back of that, we will see more facilities built.”
He knows that the need for infrastructure is urgent and that everybody has been behind the eight ball when it comes to getting new plant in place.
“Local governments have to wear some of that blame, just like state government has to wear some for why it’s so expensive, laborious and takes so long to get approvals for a resource recovery facility,” he said. “The NSW state government itself has said we’re running out of landfill space, and we haven’t approved a state land landfill
for over 25 years.
However, Pagliaro believes one of the main issues is the lack of co-ordination around what councils and the states expect from their constituents when it comes to dealing with waste. He did research that brought to light that while the different states, and to a lesser extent councils, want to be the masters of their own destinies, they need to think more about the end users – ie the ratepayers.
“While the regulation and the liability falls to state and local governments, a lot of issues around resource recovery require a national approach,” he said. “At local government level, there’s a lot we can do such as improving kerbside contamination rates etc. However, I read up that Australians are the most mobile people in the world – on average something like 39 per cent of us move every five years. If every one of those addresses was in a different council, that person would have to learn a new set of recycling rules every time they moved house. Can we really expect people to do that?

“State and federal governments want to help educate the community and get what is currently the 14 per cent contamination rate down. This contamination costs councils tens of millions through penalty rates and landfill levies.. But they can’t do this unless there’s some sort of agreement on what can and can’t be recycled across states.”
This idea has been mooted several times at the Australian Local Government Association (ALGA) meetings that occur every quarter. Pagliaro said making sure everybody’s on the same page wouldn’t be mandatory, but he hopes it will gain some momentum eventually so everybody – state, councils and communities – can see the benefit of such harmonisation.
“It could be a part of standard waste management contracts with councils across Australia,” he said. “Then state and federal governments, who do want to help educate, can support the idea through a concerted media campaign. We can’t do that because there’s no consistency. That’s what I’d like to see happen. It would help Australia go from 60 per cent to 80 per cent resource recovery. We’re not on track to do it by 2030.”

APRIL/MAY 2023 INSIDEWASTE 57 // Young Professional
Christian Pagliaro sees lack of infrastructure as the industry’s biggest issue.
Politics and plastics – the last word on REDcycle

Hi Sir
I might sound a bit flat this month. It’s been a hard road to hoe after the REDcycle scheme seems to have hit the bumpy road and gone into liquidation.
There will be lessons learned and no doubt the next entity to take up the mantle of collecting soft plastics will look to the hard-working mums at REDcycle and take what they can out of that set up to make sure it doesn’t happen again.
However, I can’t help but feel they were in a lose-lose situation. Not enough infrastructure was in place to process the plastics, but the public didn’t want them in landfill.
Let’s get this straight – a group of Melbourne mums start a recycling scheme from scratch; with little or no help from the powers that be (but who do eventually come on board); run it for the best part of the decade and try
and locate processors who can reuse this accursed waste stream; and make it known to all and sundry that the country needs more infrastructure to handle said waste stream (urgently!), and as soon as the proverbial hits the fan, the government, state agencies and retail outlets throw them under the bus? Nice. Reminds me of Goldfinger and his laser. He just wanted me dead, looks like REDcycle died a death of a thousand cuts.
And one point I keep on ramming home to my Antipodean counterparts is that this waste stream isn’t going anywhere soon. They might also want to do some research in that the amount of soft plastic waste collected by REDcycle was but a smidgen of what is out there.
Which brings me to the main point of my correspondence. Politics. Or should I say politicians. Wouldn’t it be a wonderful thing if politicians based their decisions on facts and the needs
of the people instead of the next election cycle?
“Well, JB,” I hear you say, “Isn’t that a large chunk of what this industry is based on, Old Boy? Politics?”
Yes and no. Yes, in that, sure, it is political like any industry. Especially one where a lot of government money is up for grabs in the form of grants. But no, too. When literally the whole industry –almost everybody involved – says you need more infrastructure, harmonisation, and collaboration, then surely, it’s time to look into these necessities and start doing something about it. Soft plastics are just one aspect. And don’t get me started on waste-to-energy technology that has been implemented in Northern/ Western Europe (arguably the birthplace of ‘greenies’), that can’t get a look in in Sydney. Parkes seems a spot that the bureaucrats agree on (and no doubt so does the accountant at Parkes Shire Council), but they don’t see the bigger
picture. “What bigger picture?” you say. Well, the technology is proven to have minimal impact on the environment (Ifor example, in Europe, some EfW plants don’t even show the steam they emit because they are worried the less informed think it is smoke – true story). I would love to see some forward scoped stats on the amount of diesel fumes and road wear going on as the waste is transported from Sydney to Parkes. To put it in terms you can understand, that distance is longer than it takes to go from London to Manchester. Can you imagine that – dozens, if not hundreds, of trucks a month heading up the M1/ M6 belching carbon monoxide and contributing to pothole problems? The uproar would make anti-nuke campaigns of Greenham Common in the early ‘80s look like a May Day picnic.
Food for thought, Sir.

Wasted Space // Daily news updates at www.insidewaste.com.au 58 INSIDEWASTE APRIL/MAY 2023
JB
London, Oslo and Dublin Rely on Our Energy-from-Waste Technology.

London, United Kingdom
So Does Perth.
Rockingham, Australia
Dublin, Ireland
Our solutions are based on efficient and environmentally sound in-house technology, and cover the entire life cycle of an Energy-from-Waste facility. Our proven technologies have been part of more than 700 plants worldwide. As a global leader in energy from waste we are proud to be able to say: We deliver. Check our references.



Waste is our Energy

www.hz-inova.com
Oslo, Norway
DELIVERING A GREENER FUTURE
Komptech CEA is a leading supplier of machinery and systems for the treatment of solid waste through mechanical and mechanical biological treatments, as well as the treatment of biomass as a renewable energy source. Komptech CEA is proud to provide innovative solutions for handling waste and biomass.

Komptech CEA’s extensive range of products cover all key processing steps in modern waste handling. At Komptech CEA the focus is always on innovative technology and solutions ensuring maximum benefit to the customer. Like to know more? why not speak to one of our team today?
SHREDDERS TROMMEL SCREENS STAR SCREENS WINDROW TURNERS


1300 788 757

komptechcea.com.au

TERMINATOR
Where Function Meets Technology
A slow-running, single-shaft shredder suited to all types of waste.



CRAMBO
Less Fuel, More Power
Ideal for shredding all types of wood and green cuttings.
TOPTURN X
The Ideal Combination of Performance and Design
With a sturdy frame, powerful hydraulics and large drum, the Topturn X is ready to handle any work situation.
MULTI STAR
Screening with a Star
Makes waste wood and biomass processing highly efficient.
NEMUS
Robust and Reliable
Combining the practice-proven virtues of its predecessors with new solutions for even greater performance.
AXTOR
Shredding and Chipping Made Easy
One of the most versatile machines around for processing wood and green cuttings.
















































































































































































 for Return
for Return

HAMMEL RECYCLINGTECHNIK
HAMMEL RECYCLINGTECHNIK
ECOSTAR DYNAMIC SCREENS ECOSTAR DYNAMIC SCREENS
VB750DK Primary Shredder
The Red Giant VB950DK Primary Shredder
HAMMEL RECYCLINGTECHNIK
HAMMEL RECYCLINGTECHNIK
ECOSTAR DYNAMIC SCREENS ECOSTAR DYNAMIC SCREENS
VB750DK Primary Shredder
The Red Giant VB950DK Primary Shredder





























